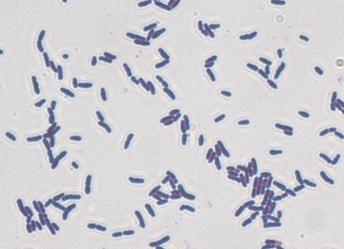
Эубактериум спп у женщин

Эубактериум спп у женщин
[Эубактериум спп у женщин]
[Эубактериум спп у женщин]
Эубактерии в мазке у женщин
Главная » Мазок » Эубактерии в мазке у женщин
Наверное, каждая представительница слабого пола хотя бы раз в течение своей жизни встречалась с такой болезнью, как бактериальный вагиноз влагалища. Этот малоприятный спутник не столько опасен своими проявлениями, сколько осложнениями, появление которых может спровоцировать.
Но наибольшую опасность данное заболевание приобретает во время беременности, поэтому требует максимальной санации микрофлоры влагалища и восстановление нормального микробиоценоза.
Что это за недуг?
Говоря о подобном заболевании – бактериальный вагиноз, имеют в виду неспецифический воспалительный синдром, при котором значительно в количественном плане изменяется микробиоценоз влагалища в сторону увеличения условно-патогенной микрофлоры за счет анаэробных бактерий и уменьшения молочнокислых бактерий или палочек Додерлейна.
Другими названиями заболевания являются гарднереллез, дисбактериоз влагалища или анаэробный вагиноз. Учитывая, что при данном процессе наблюдается многообразие микроорганизмов, название «бактериальный» вполне оправдано. Однако отсутствие в мазках признаков воспалительной реакции (лейкоцитов) термин «вагинит» претерпел изменения до «вагиноза». Встречается заболевание в 15 – 80% случаев.
Классификация влагалищного дисбактериоза
По степени тяжести в дисбактериозе влагалища различают:
- компенсированный или 1 степени (в мазке отсутствуют микрофлора, присутствуют эпителиальные клетки без изменений и сохраняется возможность инфицирования другими патогенными микроорганизмами);
- субкомпенсированный или 2 степень (снижается содержание палочек Додерлейна, увеличивается грамотрицательная и грамположительная флора, встречаются от 1 до 5 «ключевые» клетки, незначительное увеличение лейкоцитов – до 15 – 25);
- декомпенсированный или 3 степень (нет молочнокислых бактерий, налицо клиническая картина заболевания, «ключевые» клетки сплошь, различные патогенные и факультативные или условно-патогенные микроорганизмы).
По течению выделяют острый, торпидный или стертый и бессимптомный дисбактериоз влагалища.
Причины и механизм развития дисбактериоза влагалища
Известно, что влагалище заселяют лактобактерии или молочнокислые бактерии (палочки Додерлейна), функция которых заключается в переработке гликогена и синтезировании из него молочной кислоты, которая создают кислую среду, таким образом тормозя размножение факультативной и патогенной микрофлоры.
Кроме всего прочего, палочки Додерлейна вырабатывают еще и перекись водорода, обеспечивая обеззараживающий эффект. В случае снижения содержания палочек Додерлейна кислая среда (3,8 – 4,5) влагалища сдвигается в щелочную сторону, таким образом провоцируя рост условно-патогенных микроорганизмов.
Если в нормальной влагалищной микрофлоре молочнокислые бактерии находятся в количестве 95% и более от всех микроорганизмов, то оставшиеся проценты приходятся на условно-патогенную флору (бактероиды, пептококки, стафилококк и прочие).
Причины бактериального вагиноза заключаются не в размножении какого-либо одного условно-патогенного микроорганизма, а в ассоциации микробов. К ним относятся в первую очередь гарднереллы, мобилинкус и микоплазма. При данном заболевании в основном возрастает количество анаэробных (не нуждающихся в кислороде) бактерий.
Провоцирующие факторы
Все факторы, которые способствуют возникновению заболевания можно разделить на 2 группы:
Эндогенные или действующие изнутри
- лечение, особенно длительное или бесконтрольное антибиотиками
- прием цитостатиков, антимикотических препаратов и лучевая терапия (ослабление иммунитета);
- пренебрежение правилами интимной гигиены;
- чрезмерное стремление к чистоте (спринцевания, частые подмывания с мылом и влагалищные души);
- деформация вагины, шейки матки и мышц тазового дна после родов, операций или облучения;
- чужеродное тело во влагалище;
- гигиенические тампоны, диафрагма, внутриматочная спираль, шеечный колпачок;
- спермициды (см. негормональные противозачаточные средства);
- смена полового партнера;
- активная сексуальная жизнь;
- воспалительные процессы репродуктивной системы в анамнезе или имеющиеся.
Как видно из всех перечисленных факторов, заболевание не является венерическим, а, значит, не передается сексуальным путем. Активность сексуальной жизни способствует лишь заселению влагалища условно-патогенной микрофлорой, ее размножению и подавлению роста лактобактерий.
Как проявляется дисбактериоз влагалища
Симптомы бактериального вагиноза, в большинстве случаев не обладают специфическими признаками. Нередко единственным проявлением заболевания являются лишь:
жалобы на обильные влагалищные выделения, которые имеют неприятный запах
Запах описывается пациентками как тухлый рыбный «аромат» или запах аммиака (см. выделения с запахом рыбы). Это связано с выделением некоторых условно-патогенных бактериями, в частности гарднереллами, в процессе жизнедеятельности летучих аминов. В начале инфекционного процесса влагалищные бели обладают жидкой консистенцией и имеют белую либо сероватого оттенка окраску.
если у женщины бактериальный вагиноз длительное время
Если заболевание продолжается долго, более 2 лет, то:
- бели меняют свою консистенцию, становятся более тягучими или напоминают творожистую массу
- цвет выделений становится темно-зеленым
- также для выделений при дисбактериозе влагалища характерны следующие признаки: они со временем становятся густыми и липкими, а распределение их по влагалищным стенкам равномерно. Бели легко удаляются со стенок ватным тампоном.
- объем влагалищных выделений достигает 0, 02 литра в сутки (если учесть, что в норме количество белей не выше 2 – 4 мл).
- в ряде ситуаций к описываемому инфекционному процессу присоединяется патогенная флора, что способствует развитию вагинита.
- при длительно протекающем процессе ряд пациенток предъявляют жалобы на незначительный или умеренный зуд/жжение в районе вульвы (см. зуд во влагалище)
- боли в моменты сексуального контакта (см. боль при половом акте)
- иногда возникают расстройства мочеиспускания (частое и болезненное мочеиспускание у женщин).
Отличительной чертой заболевания является отсутствие видимых признаков воспаления. То есть при визуальном осмотре наблюдается физиологическая розовая окраска влагалищной слизистой. Только в некоторых случаях у женщин, находящихся в менопаузе отмечаются единичные красноватые точки.
При проведении кольпоскопии подтверждается отсутствие воспалительных проявлений (нет ни местной, ни распространенной гиперемии, точеные кровоизлияния не наблюдается, слизистая влагалища без отека и инфильтрации). Но у трети больных возможно выявление фоновых процессов шейки матки (эктропион, эктопия, цервицит) и рубцовая деформация.
Очень часты случаи диагностики данного заболевания при беременности. Особенности состояния женского организма в гестационный период таковы, что возрастает риск возникновения анаэробного вагиноза. В первую очередь возросшие шансы возникновения заболевания обусловлены увеличением в организме будущей матери продукции прогестерона, который отвечает за прогрессирование беременности, увеличение содержания слизи в шеечном канале и ее сгущения для препятствия проникновения в полость матки патогенных агентов и сдвиги рН.
Однако не все беременные рискуют заболеть дисбактериозом влагалища, что объясняется высоким содержанием молочнокислых бактерий в нем. Особую опасность представляет заболевание, диагностированное в период ожидания ребенка, которое имело место еще до беременности. В любом случае, анаэробный вагиноз требует лечения в период беременности.
Симптоматика заболевания во время беременности мало, чем отличается от клинических проявлений у небеременных женщин. Будущую мать беспокоят густые, гомогенные бели, которые обладают неприятным запахом рыбы и отличающиеся пенистостью.
Но дисбактериоз влагалища опасен своими последствиями и осложнениями как для женины, так и для будущего малыша:
- В ранних сроках заболевание может стать причиной самопроизвольного аборта.
- Во 2 – 3 триместрах может произойти инфицирование плода и/или плодных оболочек, что приведет к их преждевременному разрыву и дородовому излитию вод.
- Преждевременные роды, осложнения родового процесса и возникновение гнойно-септических заболеваний после родов – вот неполный список опасностей, которые таит в себе гарднереллез.
Как распознать дисбактериоз влагалища?
Дифференциальную диагностику заболевания проводят с воспалительными процессами влагалища (неспецифический кольпит, кандидоз, гонорея, трихомонадный кольпит). Для установления диагноза гинеколог собирает подробный анамнез, изучает жалобы пациентки.
Осмотр — во время осмотра стенок влагалища/шейки матки на вагинальных стенках обнаруживаются гомогенные (однородные) выделения в виде сливок или крема беловатого или сероватого оттенка, с неприятным рыбным букетом и в большом количестве. Это один из признаков дисбактериоза влагалища.
Мазок — вторым характерным признаком является визуализация «ключевых» клеток в нативном материале. «Ключевые» клетки представляют собой слущенные клетки эпителия с прилепленными к ним грамвариабельными бактериями (гарднерелла, мобилинкус и другие). Проведение микроскопии мазка кроме обнаружения «ключевых» клеток позволяет установить, что эпителиоциты преобладают над лейкоцитами (нет воспалительной реакции, см. причины повышения лейкоцитов в мазке) и количество палочек Додерлейна менее 5 в мазке.
Кислотность — также необходимо определить рН влагалищной среды. Для этого специальную рН-чувствительную полоску пинцетом погружают в задний влагалищный свод, где имеется наибольшее скопление выделений. Об анаэробном вагинозе будет свидетельствовать увеличение показателя рН до 4,5 и выше (третий признак).
И подтверждает диагноз возникновение тухлого рыбного запаха при смешивании влагалищных белей и 10% калиевой щелочи (КОН) в равных количествах (в результате химической реакции выделяются летучие амины).
Диагноз устанавливается при положительных трех признаков из возможных четырех.
При диагностировании бактериального вагиноза необходимо сразу же начать лечение. Успех терапии данного заболевания, как впрочем, и любого другого, напрямую зависит от верной и своевременной диагностики и назначения эффективных препаратов.
Терапию дисбактериоза влагалища осуществляют в 2 этапа:
- Первый этап – следует добиться улучшения физиологических условий влагалища, скоррегировать местные и общие защитные силы организма, а также нормализовать гормональный статус, и, конечно, ликвидировать анаэробных бактерий, как возбудителей заболевания.
- Второй этап заключается в восстановлении нормальной влагалищной микрофлоры.
Принципы лечения включают возвращение нормального микробиоценоза влагалища, создание физиологической, то есть кислой среды в нем, и, безусловно, приостановить рост и размножение бактерий, которые не свойственны здоровой влагалищной микрофлоре.
- Кроме того, в схему лечения следует включать десенсибилизирующие и иммунокорригирующие лекарственные средства.
- Назначение лечения половому партнеру нецелесообразно.
Чем лечить анаэробный вагиноз?
Чаще всего, он же является препаратом выбора, используется метронидазол (Трихопол, или его производные, который эффективен в отношении анаэробных бактерий. Также возможно применение Тинидазола или Орнидазола, Клиндамицин. Дозировка для всех перечисленных препаратов составляет 0,5 гр. дважды в сутки продолжительностью с неделю (максимум 10 дней).
При лечении метронидазолом и других активных в отношении анаэробов препаратов следует учесть возможность возникновения побочных реакций (тошнота, привкус металла во рту), а также предупреждать пациентов в отношении употребления алкоголя (запрещается прием спиртного во время прохождения курса лечения и в течение еще суток после окончания).
Не сдает позиций по эффективности от системного употребления препаратов их местное применение, особенно при выраженных побочных реакциях. Используются такие свечи от бактериального вагиноза, как: Нео-Пенотран или Клион-Д, Метрогил, Флагил, Трихопол, Клиндацин (по 1 свече интравагинально в сутки, продолжительностью 7 дней) или тампоны с гелями или кремами (Метрогил -гель, Далацин, Розамет, Розекс) см. противовоспалительные свечи в гинекологии.
Одновременно назначается витамин С (по 1 драже трижды в день), которая не только стимулирует иммунитет, но и улучшает регенерацию тканей, снижает проницаемость стенок сосудов, в результате чего уменьшается транссудация жидкости во влагалище.
Также первый этап терапии включает влагалищные инстилляции 2% молочной или борной кислоты однократно сутки на протяжении недели. Такие манипуляции способствуют созданию кислой среды, что неблагоприятно для размножения анаэробов.
Восстановление микрофлоры
На втором этапе начинают использование биопрепаратов (интравагинальное введение). Применяют апилак, ацилакт, бифидумбактерин, лактобактерин и прочие. Для этого 2 – 3 дозы разводят 5 мл кипяченой воды, промокают полученным раствором тампон и вводят интравагинально дважды в сутки (через 10 – 12 часов). Продолжительность лечения составляет 7 – 10 дней.
Можно использовать свечи:
- Бифидумбактерин (живые бифидобактерии) по 1 суппозиторию 2 р/день 5– 10 дней.
- Бификол (высушенные бифидобактерии) 7 – 10 суток.
- Ацилакт 10 дней (110 руб).
- Лактожиналь (450 руб), Вагилак (500 руб) лактобактерии, по 1 влагалищной капсуле 10 дней утром и вечером.
Лечение бактериального вагиноза при беременности
Как лечить бактериальный вагиноз в случае беременности? В первом триместре гестации системная терапия заболевания не производится (метронидазол и другие средства токсичны для эмбриона). Местное введение этиотропных препаратов на ранних сроках применяется с осторожностью.
Прием метронидазола или клиндамицина начинают со второго триместра и проводят короткими курсами. Метронидазол по 0,5 гр. (2 таблетки) дважды в сутки продолжительностью 3 – 5 дней, а клиндамицин назначается в дозировке 0,3 гр. 2 раза в день в течение 5 дней.
Меры профилактики
Для предупреждения часто повторяющихся рецидивов заболевания следует исключить беспорядочные сексуальные связи, а при случайных половых связях использовать презервативы. Также необходимо укреплять иммунитет, скоррегировать гормональный дисбаланс и эндокринные заболевания, проходить медицинские осмотры у врача-гинеколога не реже 2 раз в год.
Для укрепления местного иммунитета нашла применение вакцина Солко-Триховак, введение которой проводят внутримышечно, 3 раза через 2 недели. Через год проводится однократная ревакцинация. Введение вакцины создает иммунитет от дисбактериоза влагалища на 2 года.
Врач акушер-гинеколог Анна Созинова
zdravotvet.ru
Микрофлора половых органов у мужчин и женщин
Оглавление
Здоровье всего организма в целом определяется балансом различных микроорганизмов, которые в нем обитают. От этого же зависит и здоровье половых органов. Наверное, многие из Вас не раз сталкивались с таким понятием как микрофлора половых органов – совокупность микроорганизмов, населяющих органы мочеполовой системы человека. Сексуальное здоровье остается в норме до тех пор, пока полезные бактерии доминируют над вредными. Если же этот баланс нарушается, тогда человека начинают беспокоить разнообразные симптомы инфекционных и воспалительных недугов половых органов.Внутренние половые органы женщин представлены яичниками, маточными трубами, маткой и влагалищем. Влагалище представляет собой мышечно-фиброзную трубку, которой свойственно растягиваться. Слизистая оболочка влагалища не имеет желез, однако ей присущ плоский многослойный эпителий. Матка своим внешним видом напоминает грушу, которая уплотнена спереди назад. Располагается матка между прямой кишкой и мочевым пузырем. В состав матки входит шейка, тело и дно. Яичник – это парный орган, представляющий собой половую железу, которая размещается между двумя листками широкой связки матки. Парным органом являются и маточные трубы, которые соединяют полость матки с брюшной полостью. Их длина достигает около 12 см. Полное завершение созревания всех этих органов происходит примерно к 17 — 18 годам. На всю женскую половую систему возложена одна очень важная функция, а именно — репродуктивная. Нормальная микрофлора влагалища состоит из 90% бактерий, выделяющих кислоту. В случае если вагинальная среда по тем или иным причинам становится щелочной, тогда уровень бактерий, которые выделяют кислоту, очень сильно понижается. В итоге, слизистая оболочка влагалища подвергается воздействию целого ряда микробов, которые провоцируют развитие венерических либо воспалительных недугов. Нередко эти же микробы становятся причиной развития и рака шейки матки. Нормальной флоре влагалища свойственно все время меняться. Данный факт обусловлен наличием в клетках данного органа гликогена (полисахарида), за обмен которого отвечают женские половые гормоны. При рождении во влагалищной флоре девочек доминируют бифидобактерии и лактобациллы. Постепенно их количество снижается, вследствие чего влагалище начинает заселять кокковая флора, представленная сапрофитными и эпидермальными стафилококками. В момент полового созревания отмечается скачок половых гормонов, что, конечно же, провоцирует увеличение числа гликогена. В пожилом возрасте вновь начинает доминировать кокковая флора.Основной функцией лактофлоры влагалища является формирование особой кислой среды, которая в свою очередь выполняет свои функции, а именно:
- Эволюционную – кислой среде свойственно уничтожать сперматозоиды, вследствие чего преодолеть кислотный барьер удается только самым здоровым сперматозоидам;
- Защитную – кислая среда уничтожает все болезнетворные микроорганизмы.
Помимо этого лактофлоре влагалища свойственно повышать местный иммунитет, а именно усиливать синтез интерферона (защитного белка) и секреторных иммуноглобулинов (основного вида антител, которые принимают участие в формировании местного иммунитета). Она также провоцирует синтез макрофагов (клеток, которые активно захватывают бактерии). По составу микрофлоры выделяют следующие степени чистоты влагалища здоровых женщин:
1-я степень: кислая реакция среды, высокий уровень лактобацилл (представителей рода молочнокислых бактерий), других микроорганизмов очень мало;
2-я степень: слабокислая реакция среды, маленькое количество лактобацилл, наблюдаются стафилококки, лейкоциты и стрептококки; 3-я степень: слабощелочная либо нейтральная реакция среды, единичные лактобациллы, большое количество кокков и лейкоцитов; 4-я степень: щелочная реакция среды, лактобациллы не наблюдаются, большое количество лейкоцитов, кокков и бактероидов; 3-я и 4-я степень указывают на наличие воспалительного процесса. Явление нарушения микрофлоры влагалища именуют дисбиозом либо дисбактериозом влагалища. Существует и другое название данного состояния, а именно бактериальный вагиноз, которое особенно часто используется в медицинской практике. В нормальном состоянии влагалищная флора состоит из 90% лактобактерий, 10% бифидобактерий и менее 1% таких микроорганизмов как мобилункус, лептотрикс, гарднерелла и др. Как только равновесие между этими бактериями нарушается, женщину практически сразу же начинают беспокоить различные признаки дисбиоза, а именно:
- выделения из влагалища беловато-желтоватого окраса;
- неприятный запах;
- ощущение дискомфорта в области половых органов.
- смена климата;
- частые стрессы;
- нарушения либо изменения гормонального фона;
- инфекционные и воспалительные патологии органов малого таза;
- беспорядочная половая жизнь;
- нерациональное использование антибиотических препаратов;
- патологии кишечника;
- инфекции, передающиеся половым путем;
- переохлаждение организма;
- неправильное использование тампонов во время менструации;
- снижение иммунитета.
Так как патогенных микроорганизмов при дисбиозе достаточно много, рано или поздно они могут стать причиной развития воспалительного процесса в области как стенки влагалища, так и шейки матки. Именно с этими органами болезнетворные бактерии находятся в очень тесном постоянном контакте. Помимо этого бактерии могут проникнуть и в матку, став причиной развития эндометрита (воспаления внутренней стенки матки) либо аднексита (воспаления яичников и маточных труб). Нередко на фоне дисбиоза происходит инфицирование и мочевого пузыря, а также мочеиспускательного канала. Чтобы выявить дисбиоз влагалища, следует в самую первую очередь записаться на консультацию гинеколога. Врач осмотрит Вас и проведет все необходимые анализы:
- Общий мазок на флору – позволяет установить общее состояние влагалищной флоры и вагинальной стенки;
- ПЦР (полимеразная цепная реакция) – метод обнаружения возбудителей заболеваний передающихся половым путем по выявлению их ДНК (дезоксирибонуклеиновой кислоты) в исследуемом материале
Курс терапии дисбиоза влагалища предусматривает достижение следующих целей: 1. Подавление болезнетворных бактерий; 2. Восстановление нормальной флоры; 3. Восстановление иммунитета стенки влагалища.
1. Подавление болезнетворных бактерий:
С этой целью используются местные антисептики, антибактериальные свечи или антибиотические препараты. Что касается антибиотиков, то в их список можно занести сумамед, трихопол, амоксиклав, доксициклин и другие. Список антисептиков возглавляет мирамистин. Среди всего разнообразия антибактериальных свечей специалисты останавливают свой выбор, как правило, на гино-певариле и тержинане.
2. Восстановление нормальной флоры:
В данном случае применяются пробиотики (средства, восстанавливающие баланс микроорганизмов), в состав которых входят лактобактерии. Не обходится и без кисломолочных продуктов.
3. Восстановление иммунитета стенки влагалища:
Чтобы восстановить иммунитет стенки влагалища, пациенткам прописывают местные и общие иммуномодуляторы типа иммунала, циклоферона, полиоксидония и др. 1. Соблюдение всех правил гигиены наружных половых органов (антибактериальные средства для интимной гигиены использовать не рекомендуется, их следует заменить обычным мылом); 2. Рациональное питание, предусматривающее регулярное употребление растительной клетчатки и кисломолочных продуктов; 3. Полный отказ от самостоятельного использования антибиотиков и антибактериальных медикаментов; 4. Сведение до минимума ношения синтетического нижнего белья, особенно в жаркую погоду; 5. Регулярное использование барьерной контрацепции (презервативов); 6. Отказ от использования гигиенических прокладок и влагалищных тампонов в случае, если они хотя бы раз стали причиной развития аллергической реакции. Состав микрофлоры уретры чаще всего остается неизменным на протяжении всей жизни мужчины. Уже при рождении в уретре мальчиков имеется эпидермальный стафилококк, являющийся естественным обитателем микрофлоры здорового мужчины. Мочеиспускательному каналу присуща нейтрально-щелочная реакция, необходимая для нормального существования и размножения сапрофитных стафилококков. Эта же реакция сохраняет жизнеспособность сперматозоидов. В отличие от микрофлоры женщин мужская флора не выполняет никаких важных функций, однако она также может нарушаться, провоцируя развитие разнообразных заболеваний, одним из которых является уретрит. Уретрит представляет собой инфекционную патологию, развитие которой во всех случаях связано с инфекционным агентом в лице вирусов, грибов либо бактерий. Современные специалисты выделяют две формы данного заболевания, а именно специфический и неспецифический уретрит. Специфический уретрит является результатом одной либо нескольких половых инфекций. Неспецифическая форма данного недуга вызывается условно-патогенной микрофлорой – кишечными палочками, грибками, стрептококками, протеем, стафилококками. Перед применением необходимо проконсультироваться со специалистом.
Автор: Пашков М.К. Координатор проекта по контенту.
Вернуться к началу страницы
ВНИМАНИЕ! Информация, размещенная на нашем сайте, является справочной или популярной и предоставляется широкому кругу читателей для обсуждения. Назначение лекарственных средств должно проводиться только квалифицированным специалистом, на основании истории болезни и результатов диагностики.
www.tiensmed.ru
Дисбактериоз влагалища (бактериальный вагиноз), симптомы и лечение : Интимное здоровье
Дисбактериоз влагалища выражается в нарушении нормальной влагалищной микрофлоры. Данное заболевание встречается у большинства представительниц прекрасного пола. При этом в большинстве случаев эта болезнь проявляется в незначительной степени, однако может стать причиной развития ряда серьезных воспалительных заболеваний женской половой сферы инфекционного характера.
Стоит сразу оговориться, что для обозначения дисбактериоза влагалища может использоваться несколько терминов. Вагинальный дисбактериоз или дисбактериоз влагалища считается наиболее точным из существующих терминов, поскольку дословно в переводе обозначает нарушение микрофлоры влагалища. Но при всем при этом употребляется данный термин крайне редко. Как правило, данное заболевание называют бактериальным вагинозом, что также обозначает нарушение влагалищной микрофлоры. Между тем бактериальным вагинозом многие доктора определяют гарднереллез, являющийся частным случаем дисбактериоза влагалища. Вследствие чего, при употреблении данного термина не всегда можно быть уверенной, что именно вагинальный дисбактериоз имеется в виду.
Кроме того, достаточно часто всякого рода проявления нарушения влагалищной микрофлоры считают «кандидозом» (молочницей), что совершенно не обоснованно. Кандидоз, или молочница является проявлением одного вида нарушения микрофлоры, выражающееся в увеличении количества грибов рода Кандида, что случается крайне редко. Как правило, женщины и многие врачи молочницей называют любые влагалищные выделения, зачастую не разобравшись в природе их возникновения.
Причины нарушения влагалищной микрофлоры.
Спровоцировать развитие дисбактериоза влагалища могут различные факторы. Назовем наиболее распространенные из них:
- Преобладание во влагалище грибов рода Кандида, при этом дисбактериоз будет называться молочницей.
- Это может быть как однократное сильное, так и частое переохлаждение женского организма, которое снижает общий и местный иммунитет, что, естественно, не может не сказаться на вагинальной микрофлоре.
- Любые гормональные изменения или сбои в организме, в частности: половое созревание, нерегулярная половая жизнь, период беременности и роды, нарушения менструального цикла, аборты, предклимактерический период, климакс и т.д.
- Смена климатической зоны.
- Постоянный стресс.
- Неразборчивые половые связи с разными партнерами, пренебрежение контрацептивными средствами.
- Любые заболевания органов малого таза инфекционно-воспалительного характера.
- Половые инфекции (уреаплазмоз, трихомониаз, хламидиоз).
- Длительное или частое лечение с использованием антибиотиков.
- Кишечные заболевания, постоянные проблемы со стулом, дисбактериоз кишечника.
- Неправильное использование тампонов при месячных. Не все знают, что во время менструальных кровотечений при использовании тампонов менять их следует каждые два часа, даже ночью. Это не только неудобно, но способствует развитию прекрасных условий во влагалище для роста различных инфекций. Использование гигиенических прокладок избавит от данной проблемы.
- Это могут быть гарднереллы. В данном случае болезнь будет называться гарднереллезом (бактериальным вагинозом). Этот вид заболевания имеет чаще всего бессимптомное развитие. Лишь изредка оно может проявить себя зудом и обильными влагалищными выделениями с неприятным рыбным запахом.
- Любые микроорганизмы с патогенной активностью.
Конечно, не всегда эти факторы могут сразу вызвать бактериальный вагиноз влагалища, поскольку иммунная система отвечает за поддержание микрофлоры в нормальном состоянии, помогая ей при восстановлении в случае незначительного нарушения. Но поскольку факторов, провоцирующих возникновение бактериального вагиноза, очень много и встречаются они достаточно часто, а иммунная система не всегда может справиться со своей задачей, то развитие болезни у женщин все-таки происходит.
Механизм развития заболевания.
Нарушение вагинальной микрофлоры происходит из-за дисбаланса бактерий, который обитают во влагалище. В норме во влагалище у женщины находится около 90% полезных лактобактерий (так называемых палочек Дедерляйна), около 10% — бифидобактерий, и менее 1% «ключевые клетки влагалища» (лептотрикс, гарднерелла, грибы рода кандида, мобилункус и некоторые другие представители). Именно один из представителей ключевых клеток может стать возбудителем дисбактериоза. Кроме того, ими могут быть одна из половых инфекций или любой сапрофитный возбудитель (стрептококки, кишечная палочка, протей, стафилококки и т.д.). При нарушении микрофлоры влагалища происходит существенное сокращение количества полезных бактерий и преобладание патогенной микрофлоры.Микроорганизмы-обитатели влагалища никогда не ведут себя враждебно по отношению к стенкам влагалища, они не допускают негативного изменения соотношения полезных организмов и возбудителей. При этом активную поддержку оказывает иммунная система. Именно иммунная система помогает восстановить нормальную микрофлору при несущественных ее нарушениях. Но это бывает не всегда, к сожалению.Любой возбудитель, приведший к дисбактериозу, может спровоцировать серьезное осложнение в виде вагинита или кольпита (воспаления влагалища). Возникновение данного осложнения происходит в зависимости от количества и патогенности возбудителя, а также от того, насколько силен иммунитет стенок влагалища. Вначале защита справляется со своей задачей и препятствует прогрессированию заболевания и его осложнений. Однако, если не предпринять своевременного и грамотного лечения, то воспаление в этой ситуации просто неизбежно.
Симптомы развития заболевания и его основные осложнения.
Как уже отмечалось, вначале заболевание протекает практически бессимптомно. Изменения касаются характера выделений из влагалища, но, как правило, особенно на это внимания женщины не обращают. В норме у женщины могут наблюдаться незначительные прозрачные выделения без неприятного запаха, другого рода выделений быть не должно, как не должно быть неприятных ощущений сухости во влагалище во время интимной близости, рези, зуда и жжения во влагалище. Как правило, при дисбактериозе влагалища резко возрастает количество выделений, при этом они могут иметь беловатый или желтоватый оттенок с неприятным запахом, напоминающим протухшую рыбу. Каких-либо других симптомов при данном заболевании нет. Зуд и жжение, сухость влагалища свидетельствуют о длительности заболевания и отсутствии лечения, в результате чего развились осложнения.Вообще данное заболевание носит хронический характер, сопровождаясь периодами обострений и ремиссий. При отсутствии адекватной терапии постоянное инфицирование матки бактериями из влагалища может привести к развитию воспаления слизистой оболочки матки (эндометрита) и ее придатков (аднексита). Кроме того, длительное не лечение может способствовать развитию вагинита или кольпита, при которых выделения становятся гнойными, возникают болевые ощущения и резь в половых органах, а не редко и повышение температуры тела. Другим осложнением дисбактериоза может стать цервицит — воспаление шейки матки, при котором наблюдаются боли внизу живота, а интимная близость становится очень болезненной. Кроме того, при данном заболевании происходит постоянное инфицирование мочеиспускательного канала, что в конечном итоге приводит к развитию цистита, основными симптомами которого являются резь и жжение при мочеиспускании.
Бактериальный вагиноз влагалища при беременности.
Достаточно часто беременность становится причиной обострения бактериального вагиноза. Поскольку в этот период женский организм претерпевает огромные гормональные изменения, снижается иммунитет, меняется питание и образ жизни, то на этом фоне могут появиться или усилиться выделения, зуд или жжение в половых органах, боль во время сексуального контакта и т.д.Так как во время беременности вообще противопоказана какая-либо лекарственная терапия, то полноценного лечения получить не возможно. Любое лечение данного заболевания, даже если без применения антибиотиков, всегда сопровождается иммунокоррекцией, что в период беременности недопустимо. Именно поэтому назначается местная терапия для устранения симптомов данного заболевания.Прием антибиотиков после родов может спровоцировать дисбактериоз, который проявляется также в увеличении выделений, сухости, зуде и жжении, рези. Лечение этого заболевания у женщин в период грудного вскармливания нежелательно, поэтому назначается местная терапия, сводящая к симптоматическому лечению или, другими словами, устранению проявлений заболевания. К нему относится санации влагалища и антибактериальные свечи. Потом по окончании грудного вскармливания в случае необходимости лечение повторяется с использованием других препаратов.
Бактериальный вагиноз и половые инфекции.
Половые инфекции в любом случае имеют связь с нарушением микрофлоры влагалища. Появление половой инфекции во влагалище смещает pH, способствуя возникновению воспалительной реакции и еще большему прогрессированию заболевания.Половая инфекция всегда ассоциируется с условно-патогенной микрофлорой, поэтому это необходимо учитывать при лечении ЗППП, поскольку может быть ситуация, когда лечение антибиотиками полностью убивает возбудителя ЗППП, при этом количество условно-патогенной инфекции только растет.Окончательным этапом лечения ЗППП у женщин должно быть восстановление микрофлоры влагалища. При серьёзных инфекциях или наличии нескольких ЗППП, следует провести антибактериальную терапию и только потом заниматься восстановлением микрофлоры влагалища. В несложных случаях можно провести вначале комплексную диагностику всей урогенитальной микрофлоры, после чего заняться ее восстановлением с одновременным устранением половой инфекции.
Бактериальный вагиноз и кишечные заболевания.
При наличии выраженного дисбактериоза кишечника следует ожидать и бактериальный вагиноз. Это обусловлено тем, что стенка прямой кишки находится в плотном контакте со стенкой влагалища, в результате чего бактерии запросто проходят через нее. Как правило, из влагалища высевается одна из кишечных инфекций — кишечная палочка, энтерококки и др.В данном случае лечение имеет сложный характер, поскольку существует высокая вероятность рецидива. В данном случае восстановление нормальной микрофлоры влагалища осуществляется при одновременном лечении заболеваний кишечника.
Бактериальный вагиноз влагалища у девушек.
Данное заболевание у девушек, которые пока не ведут активную половую жизнь, встречается очень часто, что обусловлено многими факторами: это и нестабильность гормонального фона, становление менструального цикла, анатомические особенности строения девственной плевы.Бактериальный вагиноз у девушек только в редких случаях протекает с обильными выделениями, так как небольшое отверстие девственной плевы не дает им выводиться из влагалища полностью. Из-за этого возникает застой выделений во влагалище, что резко увеличивает риск развития воспалительных заболеваний. Между тем, при первой интимной близости происходит заброс большого количества бактерий из влагалища в мочевой пузырь, что может спровоцировать так называемый «цистит медового месяца».Лечение данного заболевания у девушек-девственниц затруднено строением девственной плевы, которое не дает возможности обрабатывать влагалище лекарством настолько, насколько это необходимо. Поэтому иногда врачи вынуждены прибегнуть к искусственному нарушению целостности девственной плевы (гименэктомии), чтобы провести оптимальное лечение.
Бактериальный вагиноз и половой партнер.
Нарушенная микрофлора женщины при интимной близости с мужчиной никак не сказывается на его здоровье, даже без использования контрацептивов. Очень редко в случаях выраженного дисбактериоза влагалища у мужчины может наблюдаться баланопостит и неспецифический уретрит. Однако это бывает, если у мужчины была явная предрасположенность к данным заболеваниям. Абсолютно здоровому мужскому организму эти воспалительные заболевания не страшны. В полностью здоровом организме они не разовьются.Стоит отметить, что никакие болезни партнера не сказываются на микрофлоре влагалища женщины, кроме венерических заболеваний. Лечение нарушенной микрофлоры у женщины не требует обязательного лечения полового партнера, если только у него нет половой инфекции. Поэтому обследование необходимо пройти и половому партнеру.
Диагностика заболевания.
Для опытного специалиста диагностика бактериального вагиноза не предоставит сложности. Помимо визуального осмотра, диагностика данного заболевания включает в себя взятие общего маска на флору, ПЦР-диагностику половых инфекций и посев выделений из влагалища или специальное исследование микрофлоры влагалища. Мазок показывает состояние микрофлоры влагалища и вагинальной стенки, степень их нарушения и выраженность воспалительного процесса, а диагностика половых инфекций и посев дают возможность определить возбудителей, за счет которых произошло нарушение микрофлоры, и выявить чувствительность бактерий к антибиотикам. Правильный курс лечения не может быть составлен только по одному мазку.
Лечение бактериального вагиноза должно быть комплексным и включать в себя три направления:
Подавление бактерий.
Если нарушение микрофлоры связано с наличием половой инфекции, то вначале лечение должно быть направлено на полное устранение возбудителя инфекции. В данном случае лечение заключается в приеме антибиотиков с одновременным проведением других мероприятий. Если же половых инфекций нет, то терапия антибиотиками необязательна. В данной ситуации применяется либо короткий курс антибактериальной терапии, около трех-пяти дней, либо применяется местное применение антибиотиков и антисептиков. Их действие одновременно выполняет все задачи лечения (подавление патогенной флоры, население нормальных обитателей влагалища и местная иммунокоррекция). А использование антисептиков вообще исключает вероятность невосприимчивости бактерий к ним. Для подавления болезнетворных бактерий чаще всего назначаются антибиотики (Амоксиклав, Сумамед, Доксациклин, Трихопол и т.д.), местные антисептики (Мирамистин, Хлоргексидин), антибактериальные свечи (Тержинан, Гинопеварил т. п.).
Население нормальной микрофлоры влагалища.
Этот пункт является главным в лечении дисбактериоза. Остальные мероприятия направлены на создание условий для приживления и роста нормальной флоры. Однако на практике большинство врачей пренебрегают данным этапом лечения. Для населения нормальной микрофлоры влагалища применяются массивные дозы эубиотиков (препаратов с живыми бактериями) общего и местного действия. Но применение только эубиотиков для восстановления микрофлоры без подавления возбудителей просто бесполезно.
Восстановление иммунитета стенок влагалища.
Местная иммунокоррекция должна также быть одним из этапов лечения дисбактериоза, иначе другие проведенные мероприятия не окажут ожидаемого эффекта. В несложных ситуациях для иммунокоррекции, как правило, ограничиваются применением местных иммуномодуляторов (Полиоксидоний, Циклоферон, Генферон, Иммунал), а также приемом любых пробиотиков с лактобактериями (Лактобактерин, Линекс, Нарине, Нормофлорина-ъ и т.п. Кроме того, рекомендуется включать в свой рацион питания как можно больше кисломолочных продуктов. В случаях с запущенностью заболевания восстановление иммунитета стенок влагалища потребует реализации более сложных мер.
Лечение данного заболевания чаще всего занимает около трех недель. По окончании курса лечебной терапии проводится контрольный осмотр, и сдаются контрольные анализы. Как только популяция нормальных микроорганизмов восстановится, некоторое время назначают применение специальных свечей с молочнокислыми бактериями или веществами, которые будут поддерживать их баланс. Особенно это важно женщинам в период беременности, а также тем, кто только ее планирует, поскольку дисбактериоз может спровоцировать рождение недоношенного ребенка и развитие у него инфекций после рождения, а также создать угрозу выкидыша.
Согласно народной медицины, для лечения дисбактериоза эффективны спринцевания лимонным соком, разведенным водой, молочной кислотой, а также введение во влагалище тампонов, смоченных в кефире. Все это способствует созданию кислой среды во влагалище, без которой не может быть роста и жизнедеятельности хороших лактобактерий бактерий.
Профилактика нарушения микрофлоры влагалища.
Тем, кто прошел курс лечения данного заболевания, следует обследоваться каждые три месяца в течение года. На приеме пациентка рассказывает о своем состоянии, производится осмотр и при необходимости берутся анализы. Если выявляется тенденция к нарушению микрофлоры, то назначается небольшой профилактический курс лечения. Восстановление микрофлоры на начальном этапе ее нарушения очень легко.
Если в течение года никаких серьезных проблем не возникает, то на прием к врачу можно ходить раз в полгода. Это позволяет оценить и выявить наличие тенденции к рецидиву и не допустить заболевания развития вновь.
26 апреля 2012
www.prosto-mariya.ru
Микрофлора влагалища: норма, отклонения, способы лечения
Состав микрофлоры зависит ото дня менструального цикла, возраста женщины, ее иммунного статуса, климатических условий, расовой принадлежности. Огромное влияние оказывает на нее соблюдение гигиенических мероприятий, использование средств для интимной гигиены, даже ткани, из которых изготовлено нижнее белье.
Содержание:
Влагалище заселено микрофлорой, типы которой можно классифицировать по группам:
- Облигатные микроорганизмы – они делятся на полезные, непатогенные, и условно-патогенные. Облигатная флора сохраняет нормальное состояние влагалища;
- Факультативные микроорганизмы – к ним относятся культуры, которые встречаются у каждого организма индивидуально;
- Транзиторные микроорганизмы – «чужие» микроорганизмы, занесенные случайно.
Основной микрофлорой влагалища должны быть палочки Дедерлейна или лактобактерии, которые нормализуют среду. Они закисляют влагалище, создают такой уровень РН, при котором условно-патогенные микроорганизмы активно развиваться не в состоянии, препятсвуют внедрению патогенной флоры. Часть лактобактерий синтезирует перекись водорода, создавая надежный защитный барьер.
Вместе с бифидумбактериями, которых во влагалище немного меньше, лактобактерии подавляют рост стафилококков, клебсиел и эшерихий.
Самые известные условно-патогенные микроорганизмы – гарднереллы и грибки рода кандида, патогенные – бактероиды, стрептококки, пептострептококки и стафилококки. Остальных видов микроорганизмов намного меньше.
Стоит лакто- и бифидумбактериям «сдать» позиции, происходит нарушение микрофлоры влагалища и возникают дисбактериозы – бактериальные вагиниты или вагинозы. Очень важно знать, как восстановить микрофлору влагалища, и за короткий срок. Изменение кислотности приводит к активному размножению патогенных культур и возникновению воспалительных процессов.
Если количество полезных микроорганизмов уменьшилось и болезнетворные бактерии начали усиленно размножаться, появляется дисбактериоз. Диагностируется он с помощью мазка при обычном осмотре.
Женщина обычно обращается к врачу, обнаружив у себя следующие симптомы:
- неприятный запах;
- увеличенное количество выделений;
- изменение окраски выделений на сероватые или желтоватые;
- болезненные ощущения в вульве;
- зуд.
Такая симптоматика свидетельствует о том, что на фоне дисбактериоза уже развился бактериальный вагиноз, так как начальная стадия заболевания протекает без выраженных изменений в состоянии. Чаще всего при бактериальном вагинозе в мазке обнаруживается большое количество гарднерелл или грибка рода кандида.
Болезни называют гарденелезом или молочницей. Увеличение активности патогенной флоры иного типа вызывает более тяжелые воспалительные процессы. Увеличенное количество включений ключевых клеток в мазке показывает, что начинаются воспалительные процессы.
Мазок может показать, что имеется смешанная микрофлора во влагалище. Его состояние в этом случае оценивается по количеству лейкоцитов, присутствующих в поле зрения. Эта клиническая картина считается нормой во время менструального цикла, в климактерический период, в начале полового созревания.
Наличие мелких палочек свидетельствует о начале воспалительного процесса – лактобациллы не успевают вызревать, их подавляют патогенные микроорганизмы. Необходимость лечения рассматривает врач.
Если никаких угрожающих здоровью заболеваний нет, смешанная флора корректируется с помощью препаратов, предназначенных для восстановления микрофлоры влагалища. Обнаружив у себя неприятные выделения, не следует начинать самолечение, как поступает большинство женщин, считая все густое белое отделяемое молочницей.
Некоторые венерические инфекции в начальной стадии проявляют себя подобным образом, активность кандиды проявляется на фоне размножения болезнетворных культур. Поэтому не дожидаясь нарушений менструального цикла и болей, необходимо при появлении непонятных признаков обратиться к врачу.
Дисбактериоз вызывается различными причинами:
- переохлаждением;
- гормональными нарушениями;
- приемом некоторых медицинских препаратов;
- сменой климатических условий;
- неправильным использованием тампонов;
- дисбактериозом кишечника;
- нарушением гигиенических требований;
- гинекологическими операциями;
- нерегулярной половой жизнью.
При заболеваниях венерическими инфекциями, передающихся половым путем, также возникает бактериальный вагиноз.
Чтобы нормальная микрофлора влагалища вновь защищала организм от проникновения патогенных микроорганизмов, необходимо установить причину дисбактериоза. Лечение медикаментозными средствами, необходимыми для восстановления кислой среды, подбирается в зависимости от тяжести состояния.
После того как в анализе мазка из половых органов выявлена патогенная флора, могут потребоваться дополнительные обследования: ПЦР-диагностика – выявление половых инфекций – и посев выделений, для определения чувствительности микрофлоры на антибиотики.
Препараты для восстановления микрофлоры назначаются только тогда, когда половые инфекции устранены. Если венерических заболеваний или острых воспалительных процессов не обнаружено, курс антибиотиков может не потребоваться.
Препараты, которые включаются в схему лечения бактериального вагиноза, могут быть следующими:
- Иммуномодуляторы, восстанавливающие иммунитет вагинальной стенки;
- Противовоспалительные средства местного действия в форме свечей и вагинальных таблеток, и лекарства общего действия, для перорального приема;
- Свечи, состоящие из лакто- и бифидумбактерий;
- Лекарственные средства, изготовленные по рецептам народной медицины.
Эффективно восстанавливают кислотность влагалища специальные ванночки и тампоны с лекарственными препаратами.
Раньше популярны были спринцевания, но теперь к ним стараются не прибегать. При спринцеваниях вымывается не только патогенная, но и нормальная микрофлора. Наиболее часто используются для подавления патогенных микроорганизмов свечи с метронидазолом, влагалищные таблетки и мази: «Кион-д», «Клотримаксозол», «Метронидазол», «Тержинан», «Полижинакс», и другие. Выбор подобных средств огромен, они действуют избрано на преобладающие патогенные микроорганизмы, поэтому самостоятельно назначать их не стоит.
Одновременно оказывают противовоспалительное и восстановительное действие вагинальные таблетки «Вагилак», «Гинофлор», «Экофемин» и подобные им препараты. Кроме полезных культур они имеют в своем составе йод или хлоргекседин, уничтожающие патогенные микроорганизмы. Средства, для восстановления микрофлоры влагалища, представлены свечами: «Бифидумбактерин», «Лактобактерин», «Лактоваг», «Бифолакт»…
Обычно терапевтический курс проводится по следующей схеме:
- сначала останавливается активность патогенных культур;
- затем восстанавливается нормальная кислотность влагалища.
Схема лечения инфекционных и воспалительных заболеваний подбирается индивидуально, свечи для восстановления микрофлоры вводятся курсом от 7 до 10 дней по 2 свечи в день утром и вечером.
После исчезновения основных симптомов через неделю желательно через 7 дней дополнить терапию вагинальными таблетками «Вагинорм С».
Это оптимально нормализует кислотность среды, обеспечивая быстрый рост лактобацилл.
Дисбактериоз влагалища надолго отступает при лечении по следующей схеме:
- перорально «Нормофлорины» В и Л, в течение месяца;
- 3 курса свечей «Кипферон» с перерывами на 7-10 дней.
Каким образом бы не проводилось лечение, необходимо во время него сдавать мазок – для корректировки терапевтической схемы. После того, как результаты мазка покажут восстановление нормальной микрофлоры, терапевтические мероприятия прекращаются.
Контрольный мазок сдают через 3 месяца после окончания лечения. Если его результаты нормальные, то можно считать – бактериальный вагиноз уничтожен.
mjusli.ru
Eubacterium spp в мазке что это у мужчин
Эубактерии (лат. Eubacterium) — род грамположительных строго анаэробных бактерий, типичной нормальной микрофлоры кишечника человека, составляющие значительную часть от всех населяющих желудочно-кишечный тракт микроорганизмов. Не образуют спор. Форма чаще всего палочковидная. Отличаются жёсткой клеточной стенкой.
Некоторые виды эубактерий могут преобразовывать холестерин в копростанол, участвовать в деконъюгации желчных кислот. Многие эубактерии метаболизируют углеводы и пептоны с накоплением масляной, уксусной, муравьиной и других органических кислот, используемых энтероцитами в обменных процессах. Большинство видов эубактерий (28 из 30) являются сахаролитическими, то есть способными ферментировать углеводы с накоплением смеси короткоцепочечных жирных кислот. Отдельные штаммы сахаролитических эубактерий также могут синтезировать витамины, в частности кобаламин, аминокислоты (аланин, валин, изолейцин), расщеплять целлюлозу, участвовать в обмене стероидных гормонов.
В фекалиях больных полипозом толстой кишки обнаруживается повышенное содержание Eubacterium spp. (Moore W.E., Moore L.H. Intestinal floras of populations that have a high risk of colon cancer. Appl. Environ. Microbiol. 1995; 61: 3202-3207).
Термин эубактерии (лат. Eubacterium) также употребляется как синоним термина «бактерии», обозначает домен (надцарство) прокариотных (безъядерных) микроорганизмов, чаще всего одноклеточных и подчеркивает отличие «истинных бактерий» от «архебактерий» (археев). В связи с отсутствием среди ученых единого взгляда на систематику живых организмов, термином эубактерии иногда называются другие подобные крупнейшие группы микроорганизмов.
Эубактерии — нормальная микрофлора человека
Эубактерии относятся к основной резидентной микрофлоре как тонкой, так и толстой кишки человека. Эубактерии редко встречаются у детей, находящихся на грудном вскармливании, в то же время могут выявляться у детей, находящихся на искусственном вскармливании в количестве, соответствующем норме взрослого человека. В кале здоровых людей обнаруживается следующее количество эубактерий:
- у детей первого года — 10 6 -10 7 КОЕ/г
- у детей старше года и взрослых, включая пожилых — 10 9 -10 10 КОЕ/г
Как показано на рисунке выше, эубактерии видов Eubacterium rectale и Eubacterium hallii присутствуют в заметном количестве среди других доминантных видов толстой кишки человека (данное исследование относится к английской популяции, но и в других популяциях наблюдается аналогичная картина).
Эубактерии входят в состав микрофлоры влагалища у четверти всех здоровых женщин.
Эубактерии Eubacterium ramulus, [Eubacterium] hallii (наряду с Roseburia faecis, [Eubacterium] rectale, Roseburia cecicola, Faecalibacterium prausnitzii и Coprococcus) являются основными продуцентами масляной кислоты (бутиратов) в толстой кишке. Бутираты играют важную роль в физиологии, они является основным энергетическим материалом для колоноцитов, поддерживают кишечный гомеостаз, предотвращает развития различных заболеваний кишечника.
На сайте GastroScan.ru в разделе «Литература» имеется подраздел «Микрофлора, микробиоценоз, дисбиоз (дисбактериоз)», содержащий статьи, затрагивающие проблемы микробиоценоза и дисбиоза отделов ЖКТ человека.
Эубактерии — причина заболеваний человека
Антибиотики, активные в отношении эубактерий
По современной систематике* род эубактерии входит в семейство Eubacteriaceae, порядок Clostridiales, класс Clostridia, тип Firmicutes, Terrabacteria group, царство Бактерии. Раньше род эубактерии относили к семейству Propionibacteriaceae.
В состав рода Eubacterium входят следующие виды эубактерий:
- [Eubacterium] budayi
- [Eubacterium] cellulosolvens
- [Eubacterium] combesii
- [Eubacterium] eligens
- [Eubacterium] hallii
- Eubacterium aggregans
- Eubacterium albensis
- Eubacterium barkeri
- Eubacterium brachy
- Eubacterium callanderi
- Eubacterium coprostanoligenes
- Eubacterium desmolans
- Eubacterium limosum
- Eubacterium multiforme
- Eubacterium nitritogenes
- Eubacterium oxidoreducens
- Eubacterium pectinii
- Eubacterium plexicaudatum
- Eubacterium pyruvativorans
- Eubacterium ramulus
- Eubacterium rangiferina
- Eubacterium ruminantium
- Eubacterium thermomarinus
- Eubacterium uniforme
- Eubacterium ventriosum
- Eubacterium xylanophilum
Входящий ранее в состав рода эубактерии вид Eubacterium rectale в настоящее время перенесён в семейство Lachnospiraceae этого же порядка Clostridiales. Так как вопрос с родом, к которому в рамках данного семейства должен относится этот вид, окончательно не решён, вид пока обозначается, как [Eubacterium] rectale.
Бывшие представители рода эубактерий: Eubacterium aerofaciens, Eubacterium lentum и Eubacterium timidum в настоящее время переклассифицированы как: Collinsella aerofaciens, Eggerthella lenta и Mogibacterium timidum, соответственно.
Вид Eubacterium formicigenerans перенесён в род Dorea и переименован в Dorea formicigenerans.
Виды Eubacterium moniliforme и Eubacterium tarantellae перенесены в род Clostridium и названы Clostridium moniliforme и Clostridium tarantellae.
Вид Eubacterium saphenum перенесён в семейство Clostridiales Family XIII. Incertae Sedis и именуется [Eubacterium] saphenum.
Вид Eubacterium acidaminophilum перенесён в род Peptoclostridium семейства Peptostreptococcaceae и в настоящее время именуется Peptoclostridium acidaminophilum.
Вид Eubacterium tenue перенесён в род Paeniclostridium семейства Peptostreptococcaceae и именуется [Eubacterium] tenue.
Вид Eubacterium yurii перенесён в род Peptoanaerobacter семейства Peptostreptococcaceae и именуется [Eubacterium] yurii.
Вид Eubacterium hadrum перенесён в род Anaerostipes и назван Anaerostipes hadrus.
* Исходя из соображений определённости и удобства пользования мы ориентируемся на систематику Национального центра биотехнологической информации США (National Center for Biotechnology Information), не утверждая, что она чем-то лучше или хуже других.
Источник: www.gastroscan.ru
Причины нарушения микрофлоры у мужчин
Знание и понимание причин происходящих в организме патологических процессов — первое условие успешного выздоровления. Владеющий информацией владеет миром, пусть даже в данном случае это будет мир собственного тела. Для мужчин наиболее актуальной темой остается тема здоровья мужской мочеполовой сферы.
Современная медицина смотрит гораздо глубже в корень наиболее распространенных заболеваний. Прогрессивные методы диагностики позволяют выявить самых крошечных возбудителей болезни и даже обломки их ДНК. Однако для многих мужчин и женщин до сих пор остается неясным вопрос: что может вызвать нарушение микрофлоры и превратить относительно безвредные микробиоты в инфекционных агентов? Чтобы ответ стал более понятным, необходимо немного вникнуть в тайны нормального микробиотического сообщества.
Когда микрофлора дружит с организмом
Микрофлора половых органов, как и всего тела, заселяется буквально в первые минуты после появления человека на свет: сначала микроорганизмы попадают на кожу и слизистые оболочки, а оттуда — внутрь половых органов.
У мужчин естественные микроорганизмы присутствуют в начальном отрезке мочеиспускательного канала — на расстоянии до 5 см от наружного мочеиспускательного отверстия. Большое их поселение находится в районе ладьевидной ямки, так как эта зона хуже промывается током выходящей струи мочи.
Качественный состав микрофлоры не зависит от возраста мужчины в отличие от такового у женщин и может постоянно видоизменяться, так как поселившиеся там микроорганизмы порой не задерживаются надолго.
Частые и быстрые изменения в микрофлоре происходят при постоянной смене половых партнерш, так как во время новых контактов внутрь уретры у мужчин проникают новые микроорганизмы. При моногамном образе жизни картина микробного пейзажа обычно более-менее стабильна.
Основные представители микробиотического сообщества мужских половых органов — сапрофитный и эпидермальный стафилококки. Это классические представители кокковой флоры организма, которые достаточно комфортно чувствуют себя в нейтральной или слабощелочной среде мочеиспускательного канала. Частота их выявления в мазке на флору здоровых мужчин составляет от 50 до 100%.
Несколько реже (примерно в четверти случаях) встречаются другие представители кокковой флоры — зеленящий стрептококк, фекальный энтерококк, и палочковидные бактерии: кишечная палочка, протей, бактериоидии, коринебактерии.
Еще реже (примерно у пяти мужчин из ста) встречаются золотистый стафилококк, нейссерия специес и синегнойная палочка. В редких случаях можно встретить такие патогенные микроорганизмы, как хламидия, уреаплазма, микоплазма, а также условно-патогенные грибки Кандида в составе нормальной мужской микрофлоры.
Такая разноплановая картина нормального микробиоценоза делает вполне резонным следующий вопрос: какие признаки указывают на то, что в данный момент нарушилась микрофлора и требуется заняться ее лечением?
Представители нормальной микрофлоры даже в нижних отделах уретры встречаются в достаточно низких концентрациях. Об этом судят по подсчетам микроорганизмов при исследовании окрашенного мазка и при бактериологическом посеве содержимого стенок мочеиспускательного канала.
- при исследовании окрашенных по специальным методикам стекол в норме лаборант видит до 20 представителей кокковой флоры и единичные палочки и грибки;
- при бактериологическом посеве определяют степень роста микроорганизмов; для нормального мазка характерны 1 и 2 степени, в идеальном варианте колонии бактерий растут только в жидкой питательной среде, в плотной среде роста нет, количество их очень скудное, не превышает 20 колоний; такая картина соответствует нормальной флоре или естественному бактерионосительству.
Если численные показатели различных представителей микробиоценоза значительно увеличиваются, имеет место дисбиоз половых органов. Некоторые специалисты считают дисбиозом половых органов обнаружение даже единичных представителей патогенных микроорганизмов, передающихся половым путем, и назначают в случае их выявления лечение.
При исследовании мазка на флору лаборант определяет вид и количество различных клеточных включений, и по их наличию судят о наличии воспалительного процесса. Так, в норме количество лейкоцитов не превышает 5 клеток в поле зрения, отсутствуют ключевые клетки, слизь, нейтрофилы. Если эти показатели изменились, значит, нарушилась микрофлора, и микроорганизмы спровоцировали развитие воспалительной реакции.
Таким образом, дисбиозом половых органов у мужчин является значительное увеличение числа представителей естественной флоры и патогенов, а также появление признаков воспалительной реакции при относительно нормальном микробном пейзаже.
Нормальное взаимодействие микроорганизмов друг с другом и с организмом мужчины — очень хрупкая система, которая разрушается при малейшем изменении какой-либо составляющей.
- Главной причиной нарушения микрофлоры мужских половых органов является проникновение в них (в мочеиспускательный канал) патогенных микроорганизмов, то есть инфекция, передающаяся половым путем, или нисходящая бактериальная инфекция, проникающая в уретру из воспаленных почек. Патогены нарушают равновесие. Например, влагалищная трихомонада поглощает мелких представителей микробной флоры.
- Причиной нарушения микробиоценоза может стать значительное снижение иммунной защиты организма. Иммунитет четко контролирует количество присутствующих в организме микробов и в случае, если они начинают усиленно размножаться, быстро приводит их число в норму, направляя туда защитные клетки. Если по какой-то причине иммунная система ослаблена (например, при вирусных инфекциях, переохлаждениях, травмах, когда человек проходит лечение химическими препаратами), микроорганизмы выходят из-под контроля и нарушается микрофлора.
- В мужских половых органах постоянно поддерживается относительно низкая температура, которая не позволяет усиленно размножаться присутствующим в них бактериям. Если это условие поддержания баланса микрофлоры нарушается (к примеру, при наличии воспалительного процесса в малом тазу, который повышает местную температуру), колонии кокковой флоры и палочек начинают усиленно расти.
- Противомикробным действием обладает секрет предстательной железы — он содержит комплексы веществ, имеющих выраженное антибактериальное действие. При нарушении функции простаты (к примеру, гормональной недостаточности) или при нерегулярной половой жизни не происходит естественного очищения уретры от лишних бактерий.
- Имеет значение нарушение процессов кровообращения в малом тазу, так как замедление тока крови и застой ее вызывает местное повышение температуры, что благоприятно сказывается на размножающихся микроорганизмах. Причинами расстройства регионарной гемодинамики могут стать венозная недостаточность, алкогольная интоксикация (приводящая к параличу сосудов), никотиновая интоксикация (вызывающая постоянный спазм сосудов), малоподвижный образ жизни.
- Нарушение микрофлоры у мужчины может произойти, если по каким-то причинам нарушилась микрофлора влагалища у его половой партнерши.
Выявление и устранение причины нарушения микробиоценоза половых органов — залог того, что назначенное лечение будет эффективным.
Лечение дисбиоза половых органов должно быть основано на выявлении основных нарушителей баланса микрофлоры. Так, если в мазке обнаружено большое количество грибков, лечение должно начинаться с адекватной противогрибковой терапии, а при обнаружении трихомонад лечить дисбиоз нужно теми препаратами, которые лучше всего уничтожают этих простейших.
Для того чтобы лечение банальной микрофлоры, превратившейся в патогенную, принесло наиболее выраженные и стойкие результаты, необходимо произвести посев содержимого мочеиспускательного канала с целью выделения наиболее активных представителей микробиоценоза и определения их чувствительности к антибактериальным препаратам. Без этого лечение часто бывает неэффективным, так как микроорганизмы зачастую проявляют устойчивость к наиболее распространенным антибиотикам.
Причина этого состоит в том, что человек мог принимать эти лекарственные средства для того, чтобы лечить другие соматические заболевания, нередко курс проводится не до конца, а до устранения симптомов, в результате чего бактерии приспосабливаются к поступающим в организм антибактериальным компонентам, а новые их поколения приобретают врожденную устойчивость.
При этом необязателен тот факт, что дисбиоз смогут устранить только самые новые поколения антибиотиков. Нередко при бактериологическом посеве выявляется чувствительность на самый простой и даже устаревший препарат.
Мерами профилактики дисбиоза станут известные всем, не утратившие своей актуальности рекомендации врачей:
- активный образ жизни;
- регулярная половая жизнь;
- использование средств барьерной контрацепции при новых половых контактах;
- лечение сопутствующих соматических заболеваний;
- личная гигиена;
- применение антибиотиков только по назначению врача;
- поддержание иммунной системы организма.
Нормально функционирующий организм способен регулировать свою микрофлору, поэтому в первую очередь нужно заботиться о нем.
Поделитесь ей с друзьями и они обязательно поделятся чем-то интересным и полезным с Вами! Это очень легко и быстро, просто нажмите кнопку сервиса, которым чаще всего пользуетесь:
Источник: kakbik.ru
Здравствуйте, Добрый вечер! Уже 4й год не могу завести детей. Был женат, в первом браке не мог завести детей, провели кучу исследований, ничего не помогло. Делали икси, без результата. После развода бывшая жена забеременела с первого раза через эко. Сейчас второй брак, тоже никак не можем забеременеть. Спермограмма и анализ на бактерии во вложении. Врач заставляет лечить eubacterium spp. Я почитал в инете, вроде как это женская болячка и у меня быть не должна. И на зачатие не должна влиять. Есть так же результат проверки УЗИ органов мошонки: «незначительное проявление варикоцелле».
Врач посоветовала пропить курс таблеток от eubacterium, а потом делать операцию на варикоцелле.
Не пойму — толи деньги высасывают, толи дело советуют. Что скажете?
Помогите разобраться, пожалуйста!
Что делать, если у меня похожий, но другой вопрос?
Если вы не нашли нужной информации среди ответов на этот вопрос , или же ваша проблема немного отличается от представленной, попробуйте задать дополнительный вопрос врачу на этой же странице, если он будет по теме основного вопроса. Вы также можете задать новый вопрос , и через некоторое время наши врачи на него ответят. Это бесплатно. Также можете поискать нужную информацию в похожих вопросах на этой странице или через страницу поиска по сайту . Мы будем очень благодарны, если Вы порекомендуете нас своим друзьям в социальных сетях .
Медпортал 03online.com осуществляет медконсультации в режиме переписки с врачами на сайте. Здесь вы получаете ответы от реальных практикующих специалистов в своей области. В настоящий момент на сайте можно получить консультацию по 45 направлениям: аллерголога , венеролога , гастроэнтеролога , гематолога , генетика , гинеколога , гомеопата , дерматолога , детского гинеколога , детского невролога , детского хирурга , детского эндокринолога , диетолога , иммунолога , инфекциониста , кардиолога , косметолога , логопеда , лора , маммолога , медицинского юриста , нарколога , невропатолога , нейрохирурга , нефролога , онколога , онкоуролога , ортопеда-травматолога , офтальмолога , педиатра , пластического хирурга , проктолога , психиатра , психолога , пульмонолога , ревматолога , сексолога-андролога , стоматолога , уролога , фармацевта , фитотерапевта , флеболога , хирурга , эндокринолога .
Мы отвечаем на 94.83% вопросов.
Источник: 03online.com
Что такое нормальная микрофлора половых органов
В процессе эволюции ряд микроорганизмов приспособился к обитанию в мочеполовых органов человека.Часть из них мирно сосуществует с организмом,размножается и даже выполняет весьма нужные функции .Такая микрофлора названа нормальной (естественной).Колонизация микроорганизмами половых органов происходит уже в первые часы после рождения ребенка.В основном это занос микробов из родовых путей матери и с кожных покровов.В зависимость от пола ребенка в течении определенного периода времени часть микробов погибает не найдя нужной среды обитания,другая приживается и размножается.Состав нормальной микрофлоры зависит от пола человека
Нормальная микрофлора не вызывает заболевания у человека (очень редко у больных с выраженным иммунодефицитом).В последнее время исследованиями было доказано о возникновении у некоторых женщин так называемого цитолитического вагиноза,вследствии негативного действия на эпителий влагалища лактобацилл,представителей нормальной микрофлоры.
Какой состав нормальной микрофлоры у женщин
В течении жизни женщины состав нормальной микрофлоры влагалища неоднократно меняется.Это связано с наличием в клетках влагалища особого вещества — гликогена,обмен которого регулируется эстрогенами (женскими половыми гормонами).В первые недели жизни девочки в ее крови высок процент эстрогенов,полученных от матери — поэтому количество гликогена достаточно для поддержания жизни лактобациллам,занесенных из родовых путей.Микрофлора представлена лактобациллами и бифидумбактериями,среда влагалища кислая.Далее уровень экзогенных (внешних) эстрогенов падает,лактобациллы исчезают и влагалище заселяется кокковой флорой — эпидермальными и сапрофитными стафилококками.Среда влагалища становиться щелочной.В период полового созревания начинается усиленная выработка эстрогенов,повышение количества гликогена и влагалище заселяется лакто- и бифидум-микрофлорой.Среда влагалища становиться кислой.К старости,ввиду снижения эстрогенной насышенности, уровень лактобацилл уменьшается и влагалище постепенно вновь заселяется кокковой флорой.
Нормальная микрофлора женского влагалища состоит в основном из ацидофильных лактобактерий (Lactobacilli spp),большинство из которых представлено перекись-образующими лактобациллами,небольшую часть микрофлоры составляют бифидумбактерии (до 10%) и пептострептококки (Peptostreptococcus)(до 5%).Такая смесь микроорганизмов в норме носит название микрофлора Додерлейна.Общее количество нормальных микроорганизмов не превышает 100 млн в 1 грамме вагинального отделяемого.
Состав микрофлоры влагалища здоровой взрослой женщины
Источник: venuro.ru
Eubacterium spp в мазке у женщин
Здравствуйте, сдавал анализы на ИППП, все отрицательно, кроме eubacterium spp.. Подскажите, что делать? Как лечить это?
Ответ эксперта
Добрый день, Алексей! Хочу сразу Вас успокоить, если все остальные показатели анализов на ИППП отрицательные, значит инфекции, способной передаваться половым путем, у Вас не выявлено.
Если у Вас не отмечаются какие-либо выделения, покраснения и болевые ощущения в области уретры и головки полового члена, беспокоиться не о чем. Но для того чтобы полностью удостовериться в отсутствии каких-либо проблем, связанных со здоровьем мочеполовой системы, я бы рекомендовал Вам сдать анализы повторно через 10-15 дней.
На Ваш вопрос ответил специалист:
Другие материалы из этого раздела:
- Специальность: Врач сексопатолог-андролог I категории
- Стаж работы: 29 лет
- Образование: Крымский медицинский университет им. Георгиевского
- Место работы: г. Херсон, Городской центр планирования семьи, сексологии и репродукции человека
- Специальность: Врач-уролог
- Стаж работы: 16 лет
- Образование: Московская медицинская академия им. И.М. Сеченова
- Место работы: Многопрофильный медицинский центр «IQ-CLINIC», г. Москва
- Специальность: Врач-андролог
- Стаж работы: 15 лет
- Образование: Кировская государственная медицинская академия
- Место работы: Поликлиника НИИ Физико-Химической Медицины, г. Москва
Положительный показатель eubacterium spp: что делать?
- Специальность: Врач сексопатолог-андролог I категории
- Стаж работы: 29 лет
- Образование: Крымский медицинский университет им. Георгиевского
- Место работы: г. Херсон, Городской центр планирования семьи, сексологии и репродукции человека
- Специальность: Врач-уролог
- Стаж работы: 16 лет
- Образование: Московская медицинская академия им. И.М. Сеченова
- Место работы: Многопрофильный медицинский центр «IQ-CLINIC», г. Москва
- Специальность: Врач-андролог
- Стаж работы: 15 лет
- Образование: Кировская государственная медицинская академия
- Место работы: Поликлиника НИИ Физико-Химической Медицины, г. Москва
Методика Фемофлор была представлена на международном конгрессе в 2010 году. Россия разработала свою методику в году, за что получила премию в номинации #171,Призвание#187,. Сейчас этот метод включен в новые разработки диагностических этапов в практике #171,акушерства и гинекологии#187,.
Что такое Фемофлор
Фемофлор #8212, это методика определения качественного и количественного состава флоры влагалища, основанное на методике полимеразной цепной реакции. Он позволяет наблюдать за изменениями биоценоза в #171,режиме реального времени#187,.
С помощью данного метода можно:
Как уже было сказано, основой определения биоценоза влагалища с помощью Фемофлор является метод полимеразной цепной реакции с дальнейшей амплификацией генетического материала (размножение ДНК).
Данный процесс требует определенной последовательности:
- расплетение волокон нуклеиновых кислот (ДНК),
- присоединение праймеров (затравки) для образования новых нуклеиновых кислот,
- достраивание новой цепочки ДНК по типу комплементарности.
Для проведения метода требуются определенные материалы:
Виды анализа
В разных лабораториях можно увидеть различные приставки к самому слову #171,Фемофлор#187,. Есть Фемфлор 8 (9), Фемофлор Скрин, Фемофлор 4 и анализ Фемофлор 16 (17). По сути, это один и тот же метод, только включает дополнительные реактивы на другие микроорганизмы.
В таблице можно увидеть, какие именно микроорганизмы исследуют при том или ином наборе Фемофлор.
Рассмотрим подробнее каждого представителя:
Фемофлор скрин отличается от вышеописанных анализов наличием других реактивов, способных за одно посещение к врачу исключить такие венерические заболевания, как гонорею, генитальный герпес, цитомегаловирус, трихомониаз, микоплазмоз и хламидиоз.
Показания к проведению
В связи со стоимостью процедуры провести такой анализ не каждому по карману. Поэтому врачи не разбрасываются направлениями направо и налево.
Конечно, сдать даже для профилактики такой анализ не помешает, но существуют определенные показания, которые просто требуют проведения Фемофлора:
Проведение анализа
Подготовка к анализу позволяет исключить ложные результаты. Поэтому стоит обратить внимание.
В случае запланированного анализа без наличия установленного воспалительного процесса необходимо учитывать день менструального цикла. Анализ нужно брать с пятого дня цикла, включая период до последних 5 дней перед началом месячных.
За несколько суток, не менее 48 часов до, следует исключить проведение каких-либо процедур диагностического и лечебного характера (кольпоскопия, вагинальный осмотр, биопсия), а также половой акт.
Читайте также: Апоплексия правого яичника что это такое
За сутки до взятия биоматериала следует ограничить спринцевания, введение вагинальных суппозиториев. В случае применения антибиотикотерапии желательно прекратить прием лекарств. Или проводить Фемофлор через неделю после окончания лечения.
За 2-3 часа до проведения Фемофлора нельзя ходить в туалет. Лучше подумать об этом заранее. После опорожнения тоже подмыться простой водой.
Непосредственно сама процедура занимает несколько минут. Гинеколог во время проведения общего гинекологического осмотра берет слизь со стенок влагалища в виде мазка.
Обязательно взятие материала должно быть произведено до мануального исследования. В случае загрязненности влагалища, просвет нужно очистить с помощью стерильного тампона или салфетки. Материал берут непосредственно с заднего свода зондом.
Потом зонд отправляется в пробирку с питательной средой. Материал отправляется в лабораторию на анализ.
Процесс выявления бактерий занимает 1-3 рабочих дня.
Расшифровка анализов
Далее определяется общая бактериальная масса. Она должна быть в пределах 10 6 #8212, 10 8 единиц на образец. Данный пункт показывает общую обсемененность бактериями влагалища.
Другие цифры свидетельствуют о наличии дисбиоза и снижении иммунитета: 20-60% #8212, умеренный дисбиоз, до 20% #8212, выраженный дисбиоз.
Условно-патогенная флора может присутствовать, но не должна превышать количество. В норме они составляют менее 1% от общей массы. 1-10% свидетельствуют об умеренном дисбиозе, более 10% #8212, ярко выраженный.
Патогенная флора, такая как микоплазмы, уреоплазмы и кандиды, должна отсутствовать. Даже обнаружение в минимальном количестве говорит о наличии инфекции.
Источник: www.doctornebolit.ru
Нормальная микрофлора уретры и влагалища
Многие микроорганизмы, попадающие на слизистые оболочки урогениталий, изгоняются током слизи, мочи, активностью мукоцилиарного эпителия, то есть являются транзиторнымн. Лишь те микробные виды, которые способны прикрепиться к клеткам эпителия и в этих условиях размножиться, составляют в своей совокупности нормальную микрофлору.
Если прикрепление и размножение микроорганизмов не сопровождается воспалительной реакцией, то такой проносе называют колонизацией, и напротив, если при этом происходит повреждение тканей и возникает местное воспаление — это инфекционный процесс.
Слизистые оболочки уретры и влагалища значительно отличаются по способности присоединять к своей поверхности микроорганизмы. Очень немногие клетки эпителия уретры несут на себе прикрепленные бактерии, но зато к отдельной клетке может прикрепиться множество бактерий. На слизистой оболочке влагалища много клеток, которые могут обеспечить прилипание бактерии.
На прикрепление — адгезию могут действовать многочисленные факторы, начиная с электростатических. Поскольку и клетки эпителия, и бактерии несут на себе отрицательные заряды, следовательно, на них действуют силы отталкивания, препятствующие адгезии. Энергия отталкивания снижается в кислой среде, в этих условиях можно видеть связывание бактерий. На близких расстояниях между эпителиальной клеткой и микроорганизмом действуют гидрофобно-гидрофильные отношения. Рецепторы клеток урогенитального эпителия соединяются с бактериальными лигандами, которые локализованы на фимбриях, пилях и других бактериальных приспособлениях для адгезии. Некоторые виды бактерий прикрепляются к клеткам эпителия с помощью липотейхоевых кислот.
Нормальная флора играет существенную роль в защите от патогенных видов микроорганизмов. У мужчин в уретре содержится мало видов бактерий — это Staphylococcus epidermidis, Streptococcus sp. (преимущественно зеленящие), Corynebacterium sp., Ureaplasma urealyticum в небольшом количестве. В женской уретре обычно содержится значительно больше микробных тел и, как привило, этих же комменсалов.
Напротив, во влагалище у женщин содержится огромное количество бактерии (10 8 -10 10 бактериальных тел на один грамм жидкости). Хотя наличие U.urealyticum и M.hominis связано с половым путем передачи, их роль в этиологии вагинитов и цервицитов неопределенна, часто эти виды мпкоплазм встречаются у совершенно здоровых людей. В то же время ни хламидии, ни вирусы не являются составной частью нормальной микрофлоры половых путей, хотя их часто находят у лиц без каких-либо симптомов инфекции, то есть в латентном состоянии.
Нормальная флора очень чувствительна к местным условиям и гормональным влияниям. Эстрогены способствуют депозиту гликогена, который является оптимальным субстратом для роста лактобацилл. Предполагают, что кислая среда, создаваемая за счет ферментации углеводов лактобациллами, способствует размножению кислотоустойчивых видов микроорганизмов и ограничивает рост других бактерий. Но лактобациллы продуцируют также энзимы и образуют перекись водорода, которые обладают антибиотическими (токсическими) свойствами. Низкий уровень гликогена во влагалище в период менопаузы определяется не только его дефицитом. Эстрогены, независимо от депозита гликогена, могут непосредственно влиять на численность и состав лактобацилл.
Считается, что лактобациллы осуществляют антагонизм в отношении других бактерий за счет продукции молочной кислоты, перекиси водорода, лактоцидина, ацидофиллина, лактоцина В. Интересно, что гонококки in vitro ингибируют рост лактобацилл и многих других обитателей влагалища (стафилококков, зеленящих стрептококков, грамотрицательных палочек, кандид).
Среди защитных неспецифических факторов в половых путях в первую очередь следует отметить слизь. Она секретируется на поверхности слизистых оболочек и обеспечивает ряд функций. Первой из них является любрикаиия (смазывание) и избирательное отделение эпителия от экзогенных молекул. Семя человека и цервикальный секрет содержат много слизи. Слизь во влагалище богата углеводами, которые связывают лиганды бактерий, препятствуя их адгезии к клеткам эпителия. В слизи содержатся лизоцим, лактоферрин, дефенсины — катионные антимикробные пептиды с широким спектром активности, а также цинк. Считается, что цинк в простате и ее секрете даже в низких концентрациях играет роль простатического антибактериального фактора. Содержащиеся в сперме спермидин и спермин (полиамины) бактерицидны для многих бактерии, но благоприятствуют размножению вируса иммунодефицита человека (ВИЧ).
Читайте также: Как можно заразиться молочницей женщине
Специфические иммунные механизмы слизистых оболочек полового тракта многочисленны. Иммунный ответ зависит от наличия индуктивных мест внутри эпителия. Все индуктивные места действуют в гармонии с лимфоретикулярной сетью слизистых оболочек. Антигены захватываются лнмфоиднымн клетками, макрофагами, интраэпителиальными дендритическими клетками Лангерганса. Их функциональная активность регулируется гормонами.
Эффекторные функции можно грубо подразделить на гуморальные и клеточные. Эпителий шейки и влагалища продуцирует цитокины. В эндо- и эктоцервиксе, а также в мужской уретре обнаружены плазматические клетки, продуцирующие секреторный IgА. Продукция плазматических клеток регулируется цитокинами.
Нормальная вагинальная экосистема у женшин репродуктивного возраста включает аэробные и анаэробные виды бактерий, при этом количество идентифицированных видов анаэробов значительно больше, чем аэробов. В табл.1 перечислены бактерии влагалища здоровых женщин.
Источник: bono-esse.ru
Слизистая влагалища покрыта многослойным плоским неороговевающим эпителием без желез, состоящим из нескольких слоев клеток: базальных, парабазальных, промежуточных и поверхностных. В процессе своего развития клетки из базального слоя за счет постоянного образования новых постепенно перемешаются в более верхние слои и в конце концов слушиваются, попадая в просвет влагалища. Поверхностные (или функциональные) клетки в отличие от базальиых являются плоскими, имеют сморщенное ядро и содержат большое количество гликогена. При цитолизе поверхностных клеток гликоген высвобождается из цитоплазмы и становится питательным субстратом для обеспечения энергетических и пластических процессов нормальной микрофлоры влагалища.
Нормальная микрофлора человека — это совокупность микробиоценозов, занимающих многочисленные экологические ниши на коже и слизистых оболочках. Изменение численности того или иного вида микроорганизмов в биотопе или появление не свойственных данному месту обитания бактерий служит сигналом для адаптивных или необратимых изменений в соответствующем звене микроэкологической системы. Микробиоценозы возникли в местах контакта человеческого организма с окружающей средой — на коже, слизистых оболочках желудочно-кишечного тракта, влагалища, уретры. Микробиоценоз является весьма чувствительным индикатором, реагирующим количественными и качественными изменениями на любые сдвиги внешней и внутренней среды.
Нормальная микрофлора влагалиша подразделяется на облигатную, факультативную и транзиторную. Облигатные микроорганизмы (непатогенные и условно-патогенные) в обязательном порядке входят и состав нормальной микрофлоры, препятствуют развитию попавших во влагалище патогенных микробов. Представители факультативных микроорганизмов достаточно часто, но не всегда, встречаются у здоровых женщин.
Видовой состав нормальной микрофлоры влагалища
Количественный состав нормальной микрофлоры влагалища женщин репродуктивного периода
Транзиторные микроорганизмы (непатогенные, условно-патогенные, патогенные) случайно заносятся в генитальный тракт из окружающей среды. В условиях нормального биотопа они пребывают во влагалище короткое время и быстро удаляются с током слизи и за счет деятельности мукоцилпарного эпителия. В случае нарушения защитных механизмов патогенные или условно-патогенные микроорганизмы транзиторной или факультативной флоры прикрепляются к клеткам влагалищного эпителия (адгезия) с последующим размножением и повреждением тканей (воспалительная реакция).
Влагалищная микрофлора строго индивидуальна и меняется в различные периоды развития женского организма. Понятие нормы различается не только в связи с возрастом, но и в связи с принадлежностью к разным этническим группам и даже географическим местом обитания.
Особенностью нормальной микрофлоры половых путей здоровых женщин репродуктивного возраста является многообразие видового состава, представленного широким спектром микроаэрофилов, факультативных и облигатных анаэробных микроорганизмов (соотношение «анаэробы/аэробы» в репродуктивном периоде составляет 10 : 1).
Ведущее место в вагинальном микробиоценозе — 95-98 % (10 7 -10 9 КОЕ/мл) — занимают лактобациллы (палочки Додерлейна), чаще всего это микроаэрофильные, продуцирующие перекись водорода, реже анаэробные.
Кроме влагалища различные виды лактобактерий колонизируют и дистальный отдел уретры. Комбинации видов отличаются у разных женщин.
Лактобациллы играют большую роль в поддержании нормального биоценоза влагалища за счет высокой конкуренции и антагонизма по отношению к патогенным и условно-патогенным бактериям. Защитные функции лактобактерий объясняются способностью продуцировать перекись водорода, лизоцим, что губительно влияет на патогенную флору. Кроме того, лактобациллы обладают свойством высокой адгезии к вагинальным эпителиоцитам, препятствующей колонизации патогенов и ограничивающей излишнюю пролиферацию условно-патогенных бактерий влагалища. Однако основным механизмом, обеспечивающим колонизационную резистентность вагинального биотопа, является способность лактобактерий к кислотообразованию. В результате деятельности лактофлоры из гликогена вагинального эпителия образуется молочная кислота, что и определяет кислую реакцию содержимого влагалища (рН 3,8-4,5).
Бифидобактерии, входя в состав микроценоза влагалища, также являются кислотопродуцирующими микроорганизмами, вырабатывающими, кроме того, бактериоцины, лизоиим, спирты.
Качественный и количественный состав влагалищной микрофлоры подвержен различным изменениям: так, например, в течение менструального цикла в связи с колебаниями в секреции половых гормонов дни доминирования лактобапилл сменяются днями преобладания гарлнерелл и бактероидов. Изменения вагинального биотопа и рН содержимого влагалища наблюдаются во время менструации за счет излития менструальной крови, а также после полового акта из-за щелочной реакции спермы. На состав микрофлоры влагалища, как качественный, так и количественный, могут оказывать воздействие особенности туалета половых органов, степень половой активности, а также всевозможные способы контрацепции. Снижение концентрации лактобацилл происходит при использовании внутриматочных контрацептивов, антибиотиков, антибактериальных веществ, после хирургических вмешательств, при наличии опухолевых процессов и др.
Читайте также: Атрофия яичек у мужчин
Деятельность всех биотопов, в том числе и влагалищного, регулируется эндокринной, нервной и иммунной системами, которые действуют как единое целое. Поломка в одном из этих звеньев неизменно вызывает нарушение микроэкологии влагалища, которое в дальнейшем может привести к развитию воспалительных процессов генигальпого тракта.
Плод, находясь в утробе матери, стерилен. Первичная контаминация вагинальной микрофлорой организма ребенка происходит во время родов при прохождении через естественные родовые пути. В норме влагалище новорожденных девочек в первые часы жизни стерильно. В течение первых суток влагалище девочки заселяется лактобациллами, а также другими аэробными и факультативно-анаэробными микроорганизмами из кишечника. Под влиянием материнских эстрогенов клетки вагинального эпителия накапливают гликоген, который расщепляется до лактата, создавая кислую среду. В этот период микрофлора влагалища у новорожденных девочек имеет сходство с микрофлорой здоровых взрослых женщин. Через 3 недели материнские эстрогены полностью метаболизируются, эпителий становится тонким.
Оценка степени чистоты влагалища (по А.F.М. Неиrlеin, 1910)
Источник: www.whiteclinic.ru
30 лет, 63 кг, 172 см. Начало менструаций в 14 лет. Цикл 32 дня по 7 дней: регулярно, обильно, умеренно болезненно. Последняя менструация в апреле 2011 года (далее беременность). В данный момент лактационная аменорея. Роды одни (январь 2012 года, быстрые срочные, амниоцентез, ягодичное предлежание, эпизиотомия), абортов не было.
В 2004 году электроконизация шейки матки по поводу лейкоплакии (без уточнений — карточка утеряна. Удалено было очень мало — так сказал врач). Далее при ежегодных осмотрах с помощью кольпоскопа шейка была в отличном состоянии. 2010 год: перед беременностью была ureaplasma parvum — пролечена у меня и у мужа успешно, контроль неоднократный после лечения и так же после родов, когда появились жалобы на здоровье. Перед беременностью и во время неё в остальном всё было отлично, обследование полное.
Субклинический гипотиреоз, л-тироксин 50.
Жалобы: с весны 2012 немного тянет внизу живота, в основном справа. Боль долгое время принимала за обострение травмы бедра вследствие ношения ребёнка, т.к. травма раньше похоже давала о себе знать. Выделения обычно густые сметанообразные, в маленьком количестве, без запаха, а после полового акта в течение пары дней выделения усиливаются, становятся более жидкими и могут раздражать слизистую промежности, могут иметь лёгкий кислый запах, цвет белый полупрозрачный.
6 ноября 2012: результат нативного мазка — Промежуточное состояние. дрожжевые клетки — нет, коккобациллы — нет, лактобактерии — больш, лейкоциты — умерен, мобилункусы — нет, полиморфные палочки — нет, стрептококки — нет, эпителиальные клетки — норма
6 ноября 2012: ПЦР ureaplasma spp — не обнаружены
13 ноября 2012: кольпоскопия — Эндоцервицит. Рекомендовано взять из цервикального канала на тест Фемофлор 16, анализы на ВПЧ и ИППП, сделать гинек.УЗИ.
20 ноября 2012: гинек. УЗИ. 9 месяцев после родов, лактационная аменорея. Матка в срединном положении, отклонена кпереди. Контуры чёткие, ровные. Тело матки 40*28*50мм. Структура миометрия диффузно неоднородная. М-эхо 1,7мм однородной эхоструктуры. Полость не деформирована. В базальном слое эндометрия местами единичные мелкие гиперэхосигналы d до 1мм. Длина шейки матки 26мм. Структура без особенностей. Правый яичник 28*14*20, структура нормальная. Содержит фолликулы d 3-9мм (до 4х в среде). Левый яичник 29*19*26, структура нормальная. Содержит фолликулы d 7-9мм/единичные (до 2х в среде). Свободная жидкость в полости малого таза не визуализируется.
Заключение: объемных образований в полости малого таза не выявлено.
29 ноября 2012, все взято из цервикального канала: Фемофлор 16: выявлены: Eubacterium spp. 10 в 3 степени, Atopobium vaginae 10 в 3,1 степени, а результат — Нормоценоз. ПЦР на ДНК ВПЧ тип 6, 11, 16, 18, 31, 33, 35, 39, 45, 51, 52, 56, 58, 59 — не обнаружено.
ДНК ЦМВ, ВПГ 1 и 2, Chlamidia trachomatis — не обнаружено
Вопрос: врач вообще не принял результаты Фемофлора во внимание — «я с этим не работаю». Фемофлором найдены возможные причины воспалительного процесса (ну больше некому ведь?) — Eubacterium spp. и Atopobium vaginae, а назначен Цефорал, который на них не влияет. ГВ я быстро сворачиваю. Так, может быть, пить Клиндамицин, а не Цефорал? И Клиндамицин во влагалище. И какова дальнейшая тактика? Спасибо, что прочитали.
Источник: forums.rusmedserv.com
Eubacterium: характеристика, патогенность, симптоматика, диагностика, лечение
Эубактерии — представители нормальной микрофлоры кишечника человека и влагалища здоровых женщин. Род Eubacterium состоит из 38 видов. Эти бактерии вместе с остальными анаэробами, постоянно колонизирующими слизистую оболочку, занимают биоценоз более, чем на 80%. Заселение микроорганизмами кишечника и половых органов происходит во время прохождения ребенка по родовым путям матери или сразу после его появления на свет с кожных покровов медперсонала.
Эубактерии не обнаруживаются у детей, питающихся исключительно молоком матери. У ребенка-искусственника количество эубактерии в кишечнике соответствует норме взрослого человека. У детей первого года их число составляет 106-107 КОЕ/г, у взрослых и пожилых лиц — 109-1010 КОЕ/г.
Эубактерии защищают организм человека от развития тяжелых инфекционных патологий. Они препятствуют колонизации слизистой оболочки кишечника и влагалища патогенными микробами, попавшими в организм извне. Под воздействием негативных факторов количество эубактерий стремительно возрастает. Их тотальное размножение может стать причиной кишечного дисбиоза или бактериального вагиноза.
Этиология
Эубактерии — полиморфные длинные палочковидные бактерии, окрашивающиеся по Граму в синий цвет и располагающиеся в мазке поодиночке или короткими цепочками. Их основными характеристиками являются: аспорогенность, вариабельная подвижность, способность к росту и размножению только в бескислородной среде. Они имеют жесткую клеточную стенку.
Функции микроорганизмов рода Eubacterium:
-
эубактерии под микроскопом
Пищеварительная — участие в деконъюгации желчных кислот и преобразовании холестерина.
- Метаболическая — расщепление углеводов и пептонов до органических кислот, продукция аминокислот.
- Витаминообразующая — синтез кобаламина и прочих.
- Гормональная — участие в обмене стероидных гормонов.
- Энергетическая — продукты жизнедеятельности бактерий является источником энергии для колоноцитов.
- Гомеостатическая — поддержание кишечного и вагинального гомеостаза.
- Защитная — защита слизистой оболочки от внедрения патогенных биологических агентов.
- Иммунная — активизация макрофагов, выработка интерферона и стимуляция местного иммунитета.
Современные ученые-медики доказали, что эубактерии безопасны для человека. Но в редких случаях на фоне вторичного иммунодефицита они становятся возбудителями локальных и генерализованных инфекций. Патологии, которые способны вызвать эубактерии:
- Заболевания полости рта,
- Гнойный плеврит,
- Абсцесс легкого,
- Воспаление оболочек сердца,
- Заболевания урогенитального тракта,
- Септические состояния,
- Воспаление суставов,
- Абсцедирование мозговой ткани,
- Осложнения после операций или инвазивных манипуляций.
Бактериальный вагиноз
Eubacterium spp. в анализе влагалищного секрета — признак бактериального вагиноза. Этот невоспалительный синдром возникает при резком снижении количества нормальной лактофлоры и ее замещением на микробные ассоциации.
Влагалищная микрофлора состоит из облигатных, постоянно присутствующих бактерий, а также факультативных микроорганизмов, поддерживающих местный иммунитет. К первой группе относятся лактобактерии, бифидобактерии, аэрококки, эубактерии, бактериоды, пептострептококки, гарденеллы, коринебактерии. Представителями факультативной флоры являются условно-патогенные микроорганизмы. К ним относятся: энтерококки, стрептококки, стафилококки, фузобактерии, вейлонеллы, клостридии. Важное этиологическое значение имеет несколько качественное, сколько количественное соотношение бактерий.
Тотальное размножение эубактерий происходит под воздействием провоцирующих факторов:
- Иммунодефицит,
- Соматические заболевания,
- Патологии органов репродуктивной системы,
- Травмы промежности и женских половых органов,
- Гормональный сбой,
- Длительная антибиотикотерапия,
- Плохие бытовые условия,
- Беспорядочная сексуальная жизнь,
- Частое применение лубрикантов,
- Внутриматочная спираль,
- Иммуносупрессия,
- Лечение цитостатиками.
У мужчин состав микрофлоры уретры также непостоянен. Он изменяет под воздействием неблагоприятных факторов. Дисбиоз половых органов у мужчин может быть вызван следующими причинами: ИППП, снижение иммунной защиты, дисфункция простаты, нарушение гемодинамики, бактериальный вагиноз у партнерши.
Микрофлора влагалища выполняет эволюционную функцию: оплодотворение яйцеклетки происходит только самым здоровым и сильным сперматозоидом, который сможет прорваться через кислотный влагалищный барьер. При снижении защитных сил женского организма уменьшается количество лактобактерий во влагалище. Они замещаются другими обитателями биоценоза, количество которых резко возрастает. Развивается патология. При этом отсутствует конкретный возбудитель инфекции. Снижение лактофлоры и защелачивание влагалищной среды — комфортные условия для размножения эубактерий и приобретения ими болезнетворных свойств.
Больные женщины жалуются на обилие серовато-желтых выделений из влагалища. Периодически они изменяют свою консистенцию и окраску, становятся желтыми или зеленоватыми, пенистыми или творожистыми, более густыми и липкими. Вагинальное отделяемое имеет неприятный запах, который обычно и заставляет пациентку обратиться к врачу. Подобный «аромат» обусловлен веществами, выделяемыми эубактериями и прочими микробами. Женщины ощущают дискомфорт или болезненность в области наружных гениталий после полового сношения. Жжение и зуд во влагалище, стойкое ощущение сырости в промежности, постоянное раздражение аногенитальной зоны, болезненное и учащенное мочеиспускание — клинические признаки длительно текущей патологии, приводящей нередко к тяжелым последствиям.
У беременных женщин с вагинозом намного выше риск развития воспаления половых органов, выкидышей, раннего излития амниотической жидкости, послеродового сепсиса.
Дисбактериоз кишечника
Эубактерии относятся к облигатной микрофлоре кишечника человека. Они составляют большую часть среди всех населяющих ЖКТ микробов. Эубактерии вместе с лактобактериями и бифидобактериями — основа нормоциноза кишечника, выполняющая ключевую роль в поддержании его функций. При снижении количества полезных бактерий увеличивается число условных патогенов, что приводит к развитию местного воспаления, протекающего в форме колита, энтерита или энтероколита.
Этиологические факторы дисбактериоза кишечника:
- Недоношенность,
- Позднее прикладывание ребенка к груди,
- Ранний перевод на искусственное вскармливание,
- Хронические соматические заболевания в стадии декомпенсации,
- Эндокринопатии,
- Онкопатологии,
- Антибактериальная, гормональная или химиотерапия,
- Облучение,
- Несбалансированное питание,
- Авитаминоз.
Дисбиотические нарушения — один из признаков стресса, аллергии, вирусной инфекции, нарушения обменных процессов и антагонистической дисфункции эубактерий.
Дефицит эубактери в кишечнике приводит к:
- Развитию интоксикационного синдрома,
- Метаболическим расстройствам,
- Аллергизации организма,
- Дисфункции кишечника,
- Нарушению стула,
- Плохому усвоению питательных веществ и микроэлементов,
- Уменьшению количества иммунных клеток, подавлению их активности,
- Повышению проницаемости слизистой кишечника для патогенных бактерий и токсинов.
Подобные процессы увеличивают токсическую нагрузку на печень и почки, способствуют развитию атеросклеротических изменений, психоневрологических расстройств, дисфункции сердца и сосудов, нарушению стула, недостаточности лактазы, а также повышают риск возникновения опасных для жизни осложнений.
Клинические признаки дисбактериоза кишечника зависят от глубины нарушения и состояния защитных сил организма. Существует 4 степени дисбиоза, которые отличаются количественным соотношением бактерий в кале и выраженностью основных клинических проявлений. Первая и вторая стадии отличаются умеренным снижением бактерий облигатной флоры и проявляются признаками диспепсии — отрыжкой, изжогой, тошнотой, рвотой, горечью во рту, запором или поносом, метеоризмом. Третья и четвертая стадии развиваются, когда количество эубактерий, лакто- и бифидофлоры становится критически низким, или они полностью отсутствуют. У больных помимо диспепсии возникают признаки астенизации, интоксикации, анемизации, поражаются внутренние органы — печень, почки, поджелудочная железа. Часто подобные процессы становятся необратимыми, приводят к истощению больных, развитию многообразных инфекционно-септических осложнений и даже летальному исходу.
Диагностика
Диагностика заболеваний, обусловленных эубактериями, основывается на данных, полученных в ходе микробиологического исследования кала или влагалищного отделяемого. Лабораторная диагностика — основной метод обнаружения микробов и их количественного соотношения с другими обитателями биоценоза.
Гинеколог осматривает женщину в зеркалах и отбирает материал для исследования. При этом он не обнаруживает патологических изменений, за исключением большого количества вагинального секрета, покрывающего цервикальный канал. При кольпоскопии выявляют дистрофические процессы в матке. Бактериоскопическое исследование выделений из влагалища позволяет оценить степень чистоты, количество лейкоцитов, кислотность среды.
Бактериологическое исследование отделяемого слизистой оболочки влагалища позволяет определить качественное и количественное соотношение представителей облигатной и транзиторной микрофлоры. Для выявления условно-патогенных бактерий биоматериал от больной в условиях абсолютной стерильности засевают на питательные среды, микроскопируют колонии, накапливают чистую культуру для дальнейшей работы с ней. Микробиологическое исследование — долгий и трудоемкий процесс. По количеству выросших колоний определяют степень чистоты влагалища. Норме соответствует 1 и 2 степени роста: колонии вырастают только в жидкой питательной среде, на твердых средах их количество должно быть не больше десяти. 3 и 4 степени роста — признак дисбиоза половых органов. На чашках Петри обнаруживают рост более десяти и более ста колоний соответственно.
Анализ кала на дисбактериоз позволяет определить количество эубактерий в кишечнике и установить их этиологическую роль в развитии недуга. Отбор проб проводится до начала антибиотикотерапии или спустя 10 дней после нее. За неделю до предполагаемой даты анализа прекращают прием пре- и пробиотиков, а за 2-3 дня — кисломолочных продуктов. Фекалии отбирают стерильной стеклянной палочкой из глубины исследуемого материала после естественного опорожнения кишечника в стерильную емкость. Объем образца должен быть не менее 1 грамма. Нативный кал доставляют в лабораторию в течение двух часов с момента отбора и сразу переходят к исследованию. Фекалии суспендируют физраствором и готовят ряд последовательных десятикратных разведений. Из каждой пробирки делают высев на питательные среды, селективные для определяемых бактерий. Посевы инкубируют, учитывают характер роста и подсчитывают количество колоний на чашках. Затем готовят мазки, окрашивают их по Граму, фиксируют и микроскопируют. При обнаружении в мазке эубактерий с характерными морфологическими признаками, определяют наибольшее разведение кала из которого они выросли. Все расчеты проводят по формулам, а полученные значения сравнивают с данными специально разработанных таблиц. Нарушение качественного и количественного соотношения выделенных из фекалий микроорганизмов — признак дисбиотических изменений в кишечнике.
Культуральный метод традиционно считается основой диагностики любого инфекционного заболевания. Его недостатками являются: длительность процесса культивирования микроорганизмов, сложность выращивания анаэробов, ограниченный срок транспортировки биоматериала, ориентировочная оценка количественного соотношения бактерий в биоценозе. Именно поэтому бактериологическое исследование нередко заменяют более быстрым и не менее точным диагностическим методом — ПЦР. Этот современный экспресс-метод позволяет обнаружить в исследуемом образце генетический материал бактерий Eubacterium spp. со 100% точностью.
Лечение
Вагиноз
Чтобы устранить неприятные симптомы вагиноза, вызванного эубактериями, необходимо восстановить нормальный состав биоценоза влагалища и нормализовать рН влагалищной среды. Во время проведения лечебных мероприятий женщинам рекомендуют воздержаться от половой жизни или использовать барьерные методы контрацепции.
- В отношении эубактерий активны следующие антибиотики — «Кларитромицин», «Метронидазол», «Клиндамицин». Они подавляют чрезмерный рост и размножение микробов. К современным средствам этиотропной терапии вагиноза относится комбинированный препарат «Тержинан». Это вагинальные таблетки, содержащие антибактериальный, противовоспалительный, противогрибковый, репарационный и противомикробный компоненты.
- Местное иммунокорригирующее лечение — вагинальные свечи «Кипферон», «Генферон», «Вагиферон», «Эпиген».
- Десенсибилизирующая терапия — «Кларитин», «Диазолин», «Тавегил».
- Биопрепараты для восстановления микрофлоры влагалища — интравагинальные таблетки и свечи «Лактобактерин», «Бифидин», «Ацилакт».
- Физиотерапевтическое воздействие заключается в применении низкочастотного ультразвука.
Если не лечить влагалищный дисбиоз, воспаление со слизистой оболочки влагалища распространится на цервикальный канал. Вагиноз может перерасти в эндометрит и аднексит.
Дисбактериоз
- Для нормализации количества эубактерий в кишечнике применяют пробиотики — «Энтерол», «Аципол», «Линекс», «Ацилакт», «Наринэ». Эти препараты содержат полезные микроорганизмы, которые нормализуют работу кишечника, справляясь с диареей, восстанавливая микрофлору и защищая организм от токсинов.
- Симптоматическое лечение заключается в использовании ферментных препаратов — «Креон», «Мезим», «Панзинорм», сорбентов «Смекта», «Полисорб», «Активированный уголь».
- Больным показана диетотерапия на время лечения. Лицам со склонностью к запорам специалисты рекомендуют обогащать рацион продуктами, содержащими клетчатку — отрубной хлеб, овощи, фрукты, сухофрукты, а также ежедневно употреблять молочно-кислые продукты, первые блюда на овощном бульоне, салаты с растительным маслом. Из рациона следует исключить сдобные и мучные изделия, жирные продукты, сладости. Особое внимание необходимо уделять питьевому режиму. Взрослый человек должен выпивать в сутки не менее двух литров чистой воды.
Критерии излеченности — исчезновение негативных симптомов и нормализация лабораторных показателей.
Профилактика
Мероприятия, позволяющие предупредить развитие патологий, вызванных эубактериями:
- Укрепление иммунитета путем закаливания, принятия контрастного душа, долгих прогулок на свежем воздухе, приема витаминных комплексов.
- Минимизация стрессов и негативного воздействия внешних факторов.
- Регулярная сексуальная жизнь с одним половым партнером.
- Использование презерватива при половых сношениях.
- Посещение гинеколога 1 раз в полгода.
- Своевременное лечение инфекционных заболеваний.
- Соблюдение правил личной гигиены.
- Рациональное применение антибактериальных средств, назначенных врачом.
- Восстановление гормонального фона.
- Правильное питание.
- Оптимальная физическая активность.
Эубактерии — непатогенные для человека микроорганизмы, при недостатке которых развивается особое состояние — дисбиоз, а при избытке — местное воспаление и дисфункция пораженного органа. Если патологию не корректировать, она приведет к тяжелым последствиям — заболеваниям органов пищеварения и репродуктивной системы.
Видео: микробиолог Андрей Шестаков о бактериях
Советы и обсуждение:












Комментарии 0